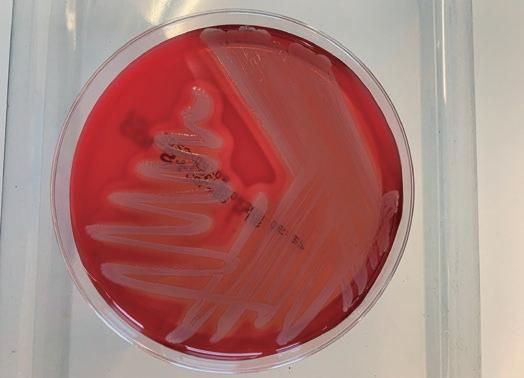

CEPAS VIRULENTAS EN ESPAÑA ¿QUÉ ESTÁ PASANDO?
“Un elefante en la granja” por Albert Finestra
Beneficios del manejo en bandas de tres semanas

“FIGAN 2023 apuesta por la sostenibilidad, la digitalización y el bienestar animal”

CURSO
Gestión de explotaciones (II). Logística y protocolos LDDD.
Franqueo concertado nº 50/202 Nº 195 - Marzo 2023 / FORMACIÓN PARA EL TÉCNICO DE PORCINO

UNA APUESTA POR LA INNOVACIÓN EN SOSTENIBILIDAD DEL PORCINO
La sostenibilidad en su más amplio sentido, ambiental, económico y social, es clave para el futuro del sector porcino y es por ello por lo que resulta de vital importancia innovar en esta área. Son numerosas las innovaciones en un sector puntero como es el porcino español y son muchas las que se centran en la sostenibilidad de sus producciones: desde novedosas técnicas para el tratamiento y reciclaje de purines y otros residuos dentro de lo que se ha dado en llamar economía circular, pasando por nuevos sistemas de obtención y control del gasto de energía y el consumo de agua, hasta la innovación relacionada con la alimentación o la sanidad, con alternativas al uso de antibióticos, o la vacuna frente al olor sexual de la carne de cerdo, por mencionar solo algunos ejemplos.
Un espíritu innovador que impulsa su crecimiento y que merece ser reconocido. Esa es precisamente la razón de ser del Premio Porc d’Or Especial Zoetis a la Innovación, tanto para el ibérico como para la producción de capa blanca, una iniciativa lanzada en 2017, con Grupo Sanchiz Godella como primera empresa reconocida precisamente por una iniciativa en el ámbito de la sostenibilidad, su programa de eficiencia energética y reducción de gases con efecto invernadero. Desde entonces, con nueve granjas reconocidas, la sostenibilidad no ha dejado de estar presente en las candidaturas presentadas y premiadas, incluida la última edición, en la que se ha alzado con el Premio Porc d’Or especial Zoetis a la Innovación, la Granja Pedregales, de Cuarte S.L (Grupo Jorge), en la provincia de Teruel, por su proyecto Porcisost, orientado a optimizar la eficiencia y sostenibilidad económica y medioambiental de la producción porcina, mediante el uso de fuentes nutricionales alternativas y subproductos industriales, la reducción del uso de antibióticos y el mejor aprovechamiento de los purines generados.
Aumentar la eficiencia productiva a través de nuevas formulaciones nutricionales, la inclusión de nuevas materias primas en la alimentación con el fin de reducir el impacto ambiental y abaratar los costes de alimentación y la mejora del aprovechamiento del purín y estiércol, de cara a su utilización agrícola, y la reducción de su impacto ambiental, son algunas de las claves que contempla el proyecto premiado.
Y, por supuesto, el jurado de los Premios Porc d´Or ha valorado muy positivamente el retorno a la inversión en un contexto de economía circular, mediante el aprovechamiento de subproductos, lo que permite reducir el volumen de residuos generados, y contribuye, junto al empleo de materias primas alternativas, a disminuir la dependencia de las importaciones en un contexto complicado como es el actual.
Desde Zoetis seguiremos con nuestra apuesta por la I+D+i en todo el proceso del cuidado de la salud animal y seguiremos también incentivando la innovación y la sostenibilidad por parte del sector porcino español, como base esencial para su crecimiento futuro.
 Francisco Fueyo Director de la Unidad de Animales de Producción Zoetis España
Francisco Fueyo Director de la Unidad de Animales de Producción Zoetis España
OPINIÓN SUIS Nº 195 Marzo 2023 ■ 3
OPINIÓN
CON NOMBRE PROPIO
6 La visión de... Albert Finestra Un elefante en la granja
ARTÍCULOS
8 Cepas virulentas de PRRSV en España. Origen, variabilidad e impacto clínico Ivan Díaz y Enric Mateu
16 Mejora de la producción basada en la implantación del manejo en bandas a tres semanas en Ibérico (I) Juan Luis Criado Rius, Juan Luis Criado Rodríguez y Silvia Astola Fonseca

APLICACIONES ESTADÍSTICAS
22 Los contajes, mejor con Poisson que con Gauss (II) Alberto Morillo Alujas, Daniel Villalba Mata y Emilio López Cano
SUMARIO
195 4 ■ SUIS Nº 195 Marzo 2023
Nº
CURSOS DE FORMACIÓN
26 Gestión de explotaciones porcinas
2ª parte: Logística y protocolos LDDD
Ángela Gallardo Marín, Emilio José Ruiz Fernández, Manuel Guerra Rico, Verónica Romera Roldán, Manuel Toledo Castillo, Elena Goyena Salgado y Jose Manuel Pinto Carrasco
ÚLTIMAS INVESTIGACIONES
36 Ensayo de una nueva vacuna frente a PRRS elaborada a partir de plantas
ENTREVISTA
38 “En esta edición hemos hecho una gran apuesta por la sostenibilidad, la digitalización y el bienestar animal”.

Javier Camo
58
62
COMITÉ ASESOR
FORMACIÓN PARA EL TÉCNICO DE PORCINO
EDITOR Julio Allué1
DIRECTOR EDITORIAL DE MEDIOS DE COMUNICACIÓN Bernardo Fuertes
Contacte con nosotros a través de suis@grupoasis.com si desea publicar un artículo, y remita sus notas de prensa a notasdeprensa@grupoasis.com
COORDINADORA DE MEDIOS DE COMUNICACIÓN Sheila Riera1
REDACCIÓN Alejandro Vicente1 Natalia Sagarra1, M. Ángel Ordovás, Israel Salvador, Sara Palasí1, Corresponsales Madrid: Raquel Sanz, Elena Manzano1
Colaboradora: Rosa Matas
RESPONSABLE DE DISEÑO Ana Belén Mombiela
JEFA DE DISEÑO Teresa Gimeno
DISEÑO Y MAQUETACIÓN Marian Izaguerri, Erica García, Marisa Lanuza Escriba a publicidad@grupoasis.com si desea anunciarse, y a suscripciones@grupoasis.com para altas, bajas o modificaciones en sus datos de contacto
RESPONSABLE PUBLICIDAD ESPAÑA Ana Caballero1
RESPONSABLE PUBLICIDAD INTERNACIONAL Jaime Panzano


PUBLICIDAD Pilar Angás1, Jorge Pérez1, Laura Montón1, Leticia Escuín1, María Puig2
SOPORTE PUBLICIDAD Raquel Miguel, Rocío Sarrate
ADMINISTRACIÓN Beatriz Sanz, Carmen Ezquerro, Miriam de la Torre
SUSCRIPCIONES suscripciones@grupoasis.com


1Licenciado/a en Veterinaria, 2Graduada en Farmacia
EMPRESA EDITORA Grupo Asís Biomedia, S.L. PREIMPRESIÓN E IMPRESIÓN Monterreina
EMPRESA MANIPULADORA Ecological Mailing S.L.

DEPÓSITO LEGAL: Z-2834/03 - ISSN: 1699-7867

Grupo Asís Biomedia está asociado a (miembro de y ) y a , (miembro de , y )
Suis está indexada en CAB Abstracts. Revista distribuida a los miembros de
Centro Empresarial El Trovador, planta 8, of. I Plaza Antonio Beltrán Martínez, 1 50002 Zaragoza (España) Tel.: 976 461 480 - Fax: 976 423 000 Email: suis@grupoasis.com Web: www.suis.grupoasis.com
Lorenzo Fraile
Carlos Piñeiro
Vicente Rodríguez-Estévez
Juan Luis Úbeda
John Carr (EE. UU.)
Marcelo Gottschalk (Canadá)
Guy-Pierre Martineau (Francia)
Santiago Vega
COMITÉ COLABORADOR

Esperanza Orellana (Directora General de Producciones y Mercados Agrarios del MAPA)
Joaquim Segalés (F.V. Barcelona, CReSA)
Eva Frontera (F.V. Cáceres)
Librado Carrasco (F.V. Córdoba)
José Poveda (F.V. Las Palmas)
Pedro Rubio (F.V. León)
Cinta Prieto (F.V. Madrid-UCM)
Francisco José Pallarés (F.V. Murcia)
María Ángeles Latorre (F.V. Zaragoza)
Marcelo de las Heras (F.V. Zaragoza)
José Luis Noguera (I.R.T.A.)
Alberto Herranz
Xavier Manteca
Miguel Ángel Higuera
Lali Coma
Emiliano de Pedro (E.T.S. Ingenieros Agrónomos y Montes de Córdoba)
Daniel Babot (E.T.S. Ingeniería Agraria de Lérida)
Antonio Torres (E.T.S. Ingenieros Agrónomos de Valencia)
Abelardo López (Asoc. Gallega de Veterinarios de Porcino)
Jesús García López (Avesa)
Junta Directiva Porcat
Junta Directiva de Anaporc
Junta Directiva de AVPA
Junta Directiva de Aveporcyl
Junta Directiva Avepomur
i+Porc (Clúster Nacional de Productores de Ganado Porcino) Porcinnova
La responsabilidad de los artículos, reportajes, comunicados, etc. recae exclusivamente sobre sus autores. El editor sólo se responsabiliza de sus artículos o editoriales. La ciencia veterinaria está sometida a constantes cambios. Así pues es responsabilidad ineludible del veterinario clínico, basándose en su experiencia profesional, el correcto diagnóstico de los problemas y su tratamiento. Ni el editor, ni los autores asumen responsabilidad alguna por los daños y perjuicios, que pudieran generarse, cualquiera que sea su naturaleza, como consecuencia del uso de los datos e información contenidos en esta revista.
De acuerdo con la normativa vigente en materia de protección de datos Grupo Asís Biomedia, SL., es responsable del tratamiento de sus datos personales con la finalidad de enviarle comunicaciones postales de nuestras revistas especializadas, así como otras comunicaciones comerciales o informativas relativas a nuestras actividades, publicaciones y servicios, o de terceros que puedan resultar de su interés en base a su consentimiento. Para ello, Grupo Asís podrá ceder sus datos a terceros proveedores de servicios de mensajería. Podrá revocar su consentimiento, así como ejercer sus derechos de acceso, rectificación, supresión, oposición, limitación y portabilidad enviando un correo electrónico a protecciondatos@grupoasis.com, o una comunicación escrita a Grupo Asís en Centro Empresarial El Trovador, planta 8, oficina I, Plaza Antonio Beltrán Martínez 1, 50002, Zaragoza (España), aportando fotocopia de su DNI o documento identificativo sustitutorio e identificándose como suscriptor de la revista. Asimismo, si considera que sus datos han sido tratados de forma inadecuada, podrá presentar una reclamación ante la Agencia Española de Protección de Datos (C/ Jorge Juan, 6. 28001 – Madrid www.agpd.es).
Queda prohibida la reproducción total o parcial del contenido de esta obra sin previa autorización escrita. La Editorial a los efectos previstos en el artículo 32.1 párrafo segundo del vigente TRLPI, se opone expresamente a que cualquiera de las páginas de esta obra o partes de ella sean utilizadas para la realización de resúmenes de prensa. Cualquier forma de reproducción, distribución, comunicación pública o transformación de esta obra solo puede ser realizada con la autorización de sus titulares, salvo excepción prevista por la ley. Diríjase a CEDRO (Centro Español de Derechos Reprográficos) si necesita fotocopiar o escanear algún fragmento de esta obra (www.conlicencia.com; 91 702 19 70 / 93 272 04 47).
ACTUALIDAD Y EMPRESAS SUIS
Sección MSD 44 Sección Boehringer 48 Sección CEVA 52 Empresas
40
empresas: Hipra
54 I+D
I+D empresas: DSM
I+D empresas: BBZix
La visión de...
UN ELEFANTE EN LA GRANJA
Estamos ante una situación muy especial en el sector porcino: los precios del animal vivo son históricamente altos; sin embargo, los márgenes de ganancia económica son muy dispares, con casos donde hay beneficios, pocos, pero en su mayoría se producen pérdidas. Y, el principal culpable es la situación sanitaria.
En estos momentos, están en boca de todo el sector los problemas de mortalidad por varios motivos como: las cepas de alta virulencia de PRRS, las diarreas posdestete, el aumento de incidencia de casos de disentería, estreptococias y muchos más. En resumen, el estado sanitario de las ganaderías y de las pirámides productivas en general está poniendo al descubierto el elefante que tenemos en nuestras granjas y el sector en general. Por poner la situación en contexto, debemos reconocer que entre todos hemos conseguido un sector profesionalizado y verticalizado, capaz de liderar la industria porcina de Europa. Pero todo lo bueno que hemos llevado a cabo no ha tenido en cuenta los elefantes internos, y ahora solo parece que veamos los problemas en los peligros externos.
El coste del deterioro sanitario
En primer lugar, estos días se ha empezado a analizar el coste aproximado que ha provocado al sector porcino el deterioro sanitario. En las IX Jornadas de SIP Consultors pudimos escuchar que podrían ser cercanos a los 300 millones de euros. Me fascinó ver cómo se hizo el silencio en la sala y ahora me pregunto si ese primer elefante lo vamos a gestionar como se debe. Con una parte de ese dinero que seguro afecta a todo el sector se podrían conseguir muchas cosas. Seguro que se podría invertir en crear equipos sanitarios para hacer análisis más certeros de la situación sanitaria de cada zona y analizar en pro-
fundidad los puntos de riesgo de entrada de nuevos patógenos y su diseminación. Se puede invertir en la comunidad científica para que busque soluciones a la medida de nuestra realidad y compatibles con la idiosincrasia del sector porcino de nuestro país. Un nuevo elefante hace referencia a la inversión en equipos veterinarios propios y ajenos de las empresas. Aquellas que tienen claro que no somos un mal necesario, sino que somos gran parte de la solución, de hecho, la más importante, son las que van a encontrar mejores y más rápidas soluciones a los problemas del sector. La gestión veterinaria es la gran diferencia entre estar en ganancias o pérdidas, ya que en los factores que afectan a la eficiencia, la información fluye de forma rápida y no hay grandes secretos. De hecho, hay pocas diferencias entre empresas. Sin embargo, en la gestión sanitaria sí se observan discrepancias importantes a la hora de entender los problemas.
La culpa siempre es de
los otros
Lo que siempre acontece cuando hay problemas de cualquier tipo es culpar a factores externos. En estos momentos, la importación de lechones, por los riesgos que conlleva, se lleva la palma. No voy a ser yo el que diga que no es así. Realmente, sería ideal que no tuviésemos que importar nada, pero ya sabemos que no va a ser así. Pero, de hecho, el sector se ha hecho grande gracias, entre otras acciones, a la importación de lechones.

6 ■ SUIS Nº 195 Marzo 2023 CON NOMBRE PROPIO
Albert Finestra Uriol Asesor veterinario
Por otra parte, si somos grandes exportadores, ¿cómo vamos a cuestionarnos la importación de nada? Lo que debemos hacer es analizar cómo hacemos esa importación y ser sabedores de que toda entrada de animales o de material genético líquido tiene un riesgo. No debe olvidarse que hacemos más de 600.000 movimientos de cerdos hacia nuestro país al año. Debemos analizarlo y controlarlo; ese es el elefante de la granja. Ser conocedores de los riesgos y controlarlos, y cuando se produzca un brote a biocontenerlo para que se disemine los menos posible.

Ser coherentes y realistas
Y para acabar esta primera reflexión del año 2023 seamos coherentes con los elefantes reales que tenemos en las granjas y seamos realistas. La formación del personal de nuestras explotaciones es básica y en estos momentos por suerte se están consolidando iniciativas muy importantes. La mano de obra debe saber en todo momento la importancia de sus acciones y qué puede ocurrir si no se cumplen con las normativas de bioseguridad. La falta de formación no se puede sustituir por tecnología, que parece que ahora está de moda. Si
no entendemos la importancia de que entrar sin cambiar en una granja es una falta grave y que hacerlo una sola vez es muy peligroso, de poco sirve que tengas un sistema de alta tecnología que nos avise.
Los riesgos no son todos de igual importancia y no podemos comparar el riesgo de una visita que se cambie de ropa con el de la recogida de cadáveres. Ambos son muy importantes, pero a veces tengo la sensación de que se cuestiona a las personas que visitamos explotaciones de forma periódica por el hecho de entrar con las gafas o un reloj, y sin embargo el camión que recoge los cadáveres entra libremente por la explotación. Y si no lo hace, no se hace ninguna gestión especial de ese espacio, que se debería considerar como una zona muy peligrosa. O como siempre decimos, pero sigue ocurriendo, la persona específica de reparación que entra con su vehículo y herramientas hasta dentro de la granja sin que nadie le impida el paso y le obligue a ponerse una ropa adecuada. Analicemos pues en profundidad los verdaderos elefantes que tenemos con la actual situación de deterioro sanitario, conozcamos dónde están los verdaderos peligros, aprendamos de ellos y pongamos los recursos donde sean necesarios. Esperemos que todo esto nos sirva de aprendizaje, que no nos visiten problemas sanitarios con muchas peores consecuencias y sigamos consolidando la posición de liderazgo.
SUIS Nº 195 Marzo 2023 ■ 7 CON NOMBRE PROPIO
Cepas virulentas de PRRSV en España. Origen, variabilidad e impacto clínico
1Licenciado en Veterinaria. Doctor en Medicina y Sanidad Animal. Investigador en IRTACReSA.
2Licenciado en Veterinaria. Doctor en Veterinaria. Profesor del Departamento de Sanidad y Anatomía Animales (UAB).
Una de las principales características del virus del PRRS (PRRSV) es su elevada variabilidad genética. Dicha variabilidad supone una perpetua expansión que facilita la aparición continua de nuevas cepas, algunas de ellas de alta virulencia. Desde el año 2020, circula en España una cepa recombinante perteneciente a un clado del virus detectado inicialmente en Italia. La cepa, comúnmente conocida como Rosalía, ha causado brotes clínicos de una gravedad no descrita antes en nuestro país, caracterizados por elevados porcentajes de abortos y mortalidades muy altas en todas las fases de crecimiento, incluso en cerdas reproductoras. En el presente artículo, resumimos los datos de los estudios realizados hasta el momento con dicha cepa, principalmente en cuanto al origen, variabilidad genética y clínica observada durante los primeros meses de aparición.
Palabras clave. PRRSV, cepas virulentas, variabilidad genética, secuenciación masiva
Virulent PRRSV strains in Spain. Origin, diversity, and clinical impact
PRRS virus is characterized by its high genetic diversity. Its diversity causes a constant expansion that facilitates the continuous emergence of new strains, some of them highly virulent. Since 2020, a recombinant strain, belonging to a clade originally detected in Italy some years ago, has been circulating in Spain. This recombinant strain, commonly known as Rosalía, has caused clinical outbreaks of a severity never described before in our country, characterized by very high percentages of abortions and high mortality in all growth phases, even in breeding sows. In this article, we summarize the data from the studies carried out to date with this strain, mainly in terms of origin, genetic and clinical variability observed during the first months of appearance.
Keywords. PRRSV, virulent strains, genetic diversity, NGS

Resumen
Summary
Ivan Díaz1 y Enric Mateu2
Contacto con los autores: Ivan Díaz, Ivan.diaz@irta.cat; Enric Mateu, Enric.mateu@uab.cat
8 ■ SUIS Nº 195 Marzo 2023 ARTÍCULOS
¿CUÁL ES EL COSTE DEL SÍNDROME REPRODUCTIVO Y RESPIRATORIO PORCINO?
RAZONES PARA ACTUAR
El PRRS es una enfermedad con un impacto económico muy elevado. Las pérdidas directas están asociadas a un cuadro reproductivo (abortos, presencia de momificados y mortinatos, nacimiento de animales débiles y un incremento de la mortalidad en lechones lactantes) y a un cuadro respiratorio. El virus del PRRS (PRRSV) es uno de los principales agentes primarios del complejo respiratorio porcino, por lo que no solo tiene un impacto directo a nivel respiratorio, sino que además facilita las infecciones bacterianas secundarias con el consiguiente aumento de mortalidad en transiciones y engordes. En cuanto a costes indirectos, cabe señalar, entre otros, los días no productivos de las cerdas abortadas, el posible aumento en el gasto en antibióticos y, en general, la distorsión que provoca al flujo de producción tanto en las gestantes como en las maternidades y transiciones. Las cifras de estudios realizados en distintos países son muy significativas: en torno a 660 millones de dólares (USD) anuales para todo el sector porcino de EE. UU.; pérdidas medias de 126 € (59 - 379 €) por cerda presente durante brotes clínicos en Holanda; 127 € por cerda presente/año y 3,8 € por cerdo en granjas con problemas reproductivos y respiratorios leves en Alemania; 205 USD por cerda presente durante brotes clínicos por PRRSV-1 en Corea del Sur. A excepción del estudio de EE.UU., el resto de los estudios mencionados evalúan el coste en granjas para cepas PRRSV-1, de virulencia muy inferior a las PRRSV-2 de alta virulencia circulantes en EE.UU. o en Asia, de las cuales podemos suponer un impacto económico mucho más elevado. Finalmente, cabe recordar que en situaciones de granjas inestables (nacimiento de lechones virémicos, pero sin clínica muy aparente), las pérdidas asociadas a esta enfermedad pueden suponer más de 75 € por cerda presente/año.
¿CÓMO APARECEN LAS NUEVAS CEPAS?
LAS FUERZAS CAUSANTES DE LA VARIABILIDAD
La actual clasificación taxonómica del PRRSV establece la existencia de dos especies, PRRSV-1 y PRRSV-2, que se
corresponden a los anteriormente denominados genotipo 1 (o Europeo) y genotipo 2 (o Norteamericano). Dentro de la especie PRRSV-1 se reconocen al menos 4 subtipos, mientras que en la especie PRRSV-2 se han descrito numerosos clados, pero no subtipos con la misma consistencia que los del PRRSV-1. Por tanto, queda patente que una de las principales características de este virus es su elevada variabilidad genética.
Las dos fuerzas principales que originan la variabilidad genética del PRRSV son la mutación y la recombinación
Las mutaciones en el genoma del PRRSV son el resultado de las características de su ARN-polimerasa. Dicha polimerasa posee una tasa de error de entre 10-3 a 10-4; es decir, comete un error en la copia del ARN cada 1.000-10.000 nucleótidos que se incorporan. Considerando que el genoma del virus contiene aproximadamente 15.000 nucleótidos, el resultado final es que todas las copias que se realizan contienen alguna mutación. Dado que la polimerasa vírica carece de capacidad para reparar los errores, estos se van acumulando a medida que el virus se va multiplicando generación tras generación. Algunas de estas mutaciones pueden resultar fatídicas para el virus si afectan de forma negativa a su replicación o a la capacidad de infectar a las células. Sin embargo, en la mayoría de los casos las mutaciones permitirán la supervivencia del virus y se irán acumulando. Este fenómeno es la causa de que cada nueva generación vírica se aleje un poco más de la variante de la que surgió. A este fenómeno se le conoce como deriva genética.
La recombinación es el intercambio de material genético entre cepas. La cepa resultante tiene partes, en diferentes porcentajes, de los parentales de los que se originó. En la mayoría de los virus ARN, la recombinación es un fenómeno que se produce durante el proceso de replicación. Durante dicho proceso, la polimerasa vírica se une a una cadena de ARN e inicia su copia. Sin embargo, la polimerasa vírica es promiscua; puede separarse fácilmente de la cadena que estaba copiando y puede unirse al ARN de otra copia del virus que esté presente en la célula. Por tanto, para que ocurra recombinación se requiere la coinfección de una misma célula con dos variantes víricas distintas.
Durante bastante tiempo se consideró que la recombinación era un fenómeno de menor importancia en la evolución del PRRSV. Evidentemente, la bibliografía se ha centrado en la aparición de recombinantes principalmente cuando han dado lugar a problemas graves, pero es un fenómeno mucho más común de lo que podríamos pensar. De hecho, mediante el uso de la secuenciación masiva se ha demostrado que la recombinación es uno de los motores de la diversificación genética del PRRSV. Así, se han descrito fenómenos de recombinación entre cepas de campo, entre cepas de campo y vacunas, y entre vacunas. Cabe destacar que el resultado de una recombinación no puede predecirse, y su impacto a nivel clínico o epidemiológico es muy variable.
Tanto la mutaciones como las recombinaciones son dos fenómenos naturales e intrínsecos de la evolución de los virus ARN. Sin embargo, en cuanto a la recombinación, ciertas prácticas a nivel de campo pueden aumentar/ disminuir la probabilidad de que esta ocurra:
1. Entradas laterales de nueva cepas => maximizar la bioseguridad externa.
2. Uso simultáneo o inmediatamente consecutivo de diferentes vacunas vivas => No usar dos vacunas vivas diferentes al mismo tiempo. Realizar periodo washout si se decide cambiar de vacuna. Realizar RT-PCR tras washout para descartar la existencia de la anterior vacuna.
3. Vacunación de animales virémicos => monitorizar lechones para establecer si la granja es estable o no; no vacunar lechones en situación de inestabilidad.
Otra medida a considerar es la monitorización mediante secuenciación de genoma completo durante los brotes clínicos y de forma regular, sobre todo si se vacuna a los lechones de forma masiva.
Prácticas que pueden aumentar/disminuir la probabilidad de recombinaciones
SUIS Nº 195 Marzo 2023 ■ 9 ARTÍCULOS
¿QUÉ CARACTERIZA A LAS CEPAS VIRULENTAS? CEPAS VIRULENTAS
PRRSV-1 Y PRRSV-2
La variabilidad genética del virus se traduce también en variabilidad en términos de virulencia. En general, se ha considerado que las cepas PRRSV-2 son más virulentas que las PRRSV-1, principalmente a nivel respiratorio. Además, las primeras cepas de alta virulencia fueron descritas para PRRSV-2, en EE.UU. (1995) y en Asia (2006). Sin embargo, se ha observado que también algunas cepas de PRRSV-1 pueden ser muy virulentas, tanto de los subtipos 2 y 3 del este de Europa (por ejemplo, las cepas Lena, SU1-bel y Bor59) como del subtipo 1.1 (cepas PR40 en Italia y AUT15-33 en Austria). Aunque no existe una nomenclatura consensuada (atípicas, de virulencia atípica, altamente patógenas, etc.), se ha propuesto el término “virulentas” para denominar de forma general a estas cepas. El término altamente virulentas/patógenas (highly-pathogenic, HP) deberíamos reservarlo para las cepas HP-PRRSV-2. En el caso de las cepas virulentas PRRSV-1, los brotes se caracterizan por un alto porcentaje de abortos, cuadros respiratorios graves, fiebre alta y duradera, y alta mortalidad en todas las edades (> 20 %), incluso en cerdas reproductoras. En cuanto a las lesiones, puede
observarse neumonía intersticial grave con infecciones bacterianas secundarias, atrofia de timo, petequias y hemorragias multifocales. Desde el punto de vista virológico, estas cepas tienen una mayor capacidad de replicación en un rango más amplio de tipos celulares, posiblemente más allá de los macrófagos alveolares, lo cual provoca viremias más largas y mayores cargas virales. Finalmente, se ha descrito que pueden inducir una liberación importante de citocinas proinflamatorias, que, junto a la muerte celular, provocan daño tisular (lesiones descritas) y facilitan las infecciones secundarias. Como puede observarse, una de las principales características de estas cepas es su capacidad de provocar daños graves en localizaciones diferentes al pulmón. De hecho, se ha demostrado que algunas son capaces de replicarse en tejidos que no suelen ser los comunes de este virus. No ha podido establecerse con claridad qué parte del virus determina la virulencia de estas cepas. De hecho, se ha observado que distintas proteínas pueden ser las responsables (nsp3-8, nsp9, GP2, GP5, etc.), por lo que probablemente la virulencia tenga un origen multigénico. Por tanto, secuenciando no podemos predecir la virulencia de una cepa, más allá de saber si se parece o no a las cepas virulentas ya existentes.

CEPAS PRRSV-1 VIRULENTAS EN ESPAÑA
En España y en años recientes, la primera cepa que podemos denominar como virulenta sea quizá la descrita en enerofebrero de 2019. Comúnmente conocida como Bisbal, esta cepa se localizó en Aragón, Cataluña, Navarra y Andalucía, y se caracterizaba por provocar problemas graves reproductivos y respiratorios, con frecuentes complicaciones bacterianas. Sin embargo, no existen muchos datos más allá de los clínicos, por lo que se desconoce su origen. La cepa fue poco a poco perdiendo fuerza en cuanto a prevalencia y gravedad de los brotes, aunque aún puede detectarse de forma minoritaria. Un desarrollo bien distinto es el que ha tenido la cepa que se detectó por primera vez a principios de 2020 en el nordeste de Cataluña. Esta cepa provocó desde el inicio brotes virulentos caracterizados por altas tasas de abortos, que en algunas granjas superaron picos del 50 % semanal, y mortalidades que frecuentemente superaban el 20 % en las transiciones y llegaban al 10 % o más en los engordes. Se observó también una mortalidad en cerdas reproductoras que llegaba a picos del 10 %. En algunas granjas afectadas, la muerte de cerdas, el alto porcentaje de abortos y la mortalidad perinatal provocó que en lotes enteros no se destetará un solo lechón.
principal pertenece al clado de una cepa italiana (80 % del genoma en 5 segmentos), seguida de tres supuestas secuencias parentales menores: Olot-91 (11 % del genoma en 2 segmentos), D40 (7 % del genoma en único segmento) y una cepa desconocida (2 % del genoma en un único segmento). Todas ellas
Cepa italiana virulenta (PR40-2014)
Cepa probablemente local, derivada de Olot-91
Cepa PRRSV1 de Korea (D40-2017) (sin información clínica)
Cepa de origen desconocido
(Martín-Valls y col., 2022).
La principal cepa parental de Rosalía es una cepa derivada de la cepa PR40, una cepa aislada en un destete de Italia. Los brotes clínicos iniciales de PR40 se caracterizaron por fiebre alta, signos clínicos sistémicos y respiratorios graves y una alta mortalidad en lechones en crecimiento (hasta 50 %). En estudios posteriores, se observó que los animales infectados presentaban atrofia de núcleos germinales en timo y linfonodos bronquiales y linfocitopenia, la cual podría deberse a una potencial depleción de linfoctios Tγδ, T CD4+ y linfocitos B.
Figura 1a. Patrón de recombinación de la cepa Rosalía a partir de 28 secuencias completas procedentes de once granjas de reproductoras (febrero-noviembre 2021).
La supuesta secuencia parental
son PRRSV-1
10 ■ SUIS Nº 195 Marzo 2023 ARTÍCULOS

La cepa causante de estos brotes se conoce popularmente como Rosalía. El análisis genético demostró que Rosalía es una cepa recombinante cuyo parental principal es una cepa del clado derivado de la cepa PR40, aislada en Italia en 2014 (figuras 1a y 1b). Muy probablemente, algunas de las recombinaciones que presenta Rosalía tuvieron lugar ya en territorio español. En pocos meses, esta cepa se extendió por gran parte de Cataluña y Aragón y, en menos de un año, se impuso a las cepas presentes con anterioridad, llegando al pico de detección en todas las zonas descritas en diciembre de 2021. Así, en 2020 menos del 9 % del total de las cepas secuenciadas correspondían a Rosalía, mientras que en 2021 fueron más del 30 %. Actualmente, se ha detectado en Cataluña, Aragón, Castellón, y en algunas de regiones de Castilla y León, aunque no podemos descartar otras localizaciones. La extensión de la diseminación puede haberse infravalorado, ya que los brotes actuales pueden ser menos alarmantes que los iniciales. Además, se suele secuenciar solo la ORF5, con los problemas de interpretación que ello conlleva (figura 2). En un estudio en el que se analiza los brotes observados desde diciembre de 2020 hasta octubre de 2021 en un sis-

tema de producción en pirámide (7.600 cerdas en 4 núcleos y 13.000 cerdas en las multiplicadoras) se detectaron hasta cuatro clados diferentes de esta cepa, probablemente debido a eventos independientes de entradas laterales. El primer caso
detectado en este sistema de producción estuvo probablemente relacionado con una granja de engorde próxima y ajena al sistema, en la cual poco tiempo antes se había reportado una mortalidad alta y repentina, supuestamente relacionada con PRRSV. En la granja de cerdas, estable a PRRS y con protocolo de vacunación, la entrada de la nueva cepa tuvo un impacto devastador, con una diseminación explosiva. La mortalidad semanal en cerdas fértiles fue del 6,5 % de media durante 39 semanas y la media de abortos del 27 % durante 17 semanas, llegando a picos del 70 %. En dos granjas que se infectaron posteriormente el impacto fue menor, pero más duradero; para algunos parámetros como la proporción de momificados o el número de nacidos muertos se necesitó un lapso mayor para poder regresar a los valores obtenidos antes del brote. En cuanto a las transiciones, la mortalidad alcanzó valores muy elevados, necesitándose muchos meses para volver a la normalidad. La tabla resume todos estos datos. Como podemos observar, incluso durante los primeros brotes existieron diferencias. A pesar de ello, la virulencia de esta cepa es más que evidente. Si comparamos los resultados obtenidos en dicho estudio con los publicados sobre PRRSV-2, podemos concluir que en algunos casos la mortalidad es superior a las cepas promedio de PRRSV-2 y que, en

BearFotos/shutterstock.com 12 ■ SUIS Nº 195 Marzo 2023
Figura 1b. Árbol filogenético que incluye 28 secuencias completas de Rosalía. El clado Rosalía está marcado en rojo y las tres cepas parentales putativas están marcadas en verde (Martín-Valls y col., 2023).
ARTÍCULOS

La ORF5 de la cepa problema es un recombinante de las cepas A (verde claro) y B (verde oscuro). El fragmento que corresponde a más de la primera mitad de la ORF5 tiene como origen la cepa A, mientras que la parte final pertenece a la cepa B. Si analizáramos tan solo la ORF5, su posición en un árbol filogenético estaría a medio camino entre ambas cepas y su similitud con A y B sería relativamente baja. En consecuencia, no podríamos definir claramente su origen. Otros segmentos del genoma podrían derivar de A, de B o incluso de otras cepas, pero no puede saberse al no haberse secuenciado el genoma completo.
La cepa problema es un recombinante de las cepas A (verde claro) y B (verde oscuro). Así, la ORF5 entera y la mitad de la ORF6 proceden de la cepa B, mientras que el resto del genoma (> 90 %) tiene como cepa parental la cepa A. Usando únicamente la secuenciación de la ORF5 agruparíamos la cepa problema con la cepa B. Sin embargo, la cepa problema es en su mayor parte más parecida a la cepa A que a la B. En este caso, ni siquiera podríamos determinar que la cepa problema se trata de una cepa recombinante.


Obviamente, los errores de interpretación cometidos en ambos ejemplos pueden solventarse si se obtuviera la secuencia completa del virus.
otros casos, generalmente más recientes, la mortalidad es inferior, pero se necesita más tiempo para volver a valores previos al brote. En general, parece que la gravedad en algunos casos actuales está disminuyendo, estando por debajo de la observada al inicio. Quizá esto se deba a un proceso de selección de variantes virales que favorece la persistencia en el rebaño. Respecto a la variabilidad genética de los diferentes aislados de la cepa Rosalía, se ha observado una variabilidad muy elevada en relación con el relativamente poco tiempo que lleva circulando. En primer lugar, tiene una mayor deriva genética anual. En el único estudio publicado hasta la fecha sobre el impacto clínico de esta cepa y la comparativa entre aislados a nivel de todo el genoma, se ha demostrado que en las granjas analizadas la tasa de sustitución anual de nucleótidos de Rosalía es del 0,33-1,1 %, frente al 0,030,17 % de las cepas detectadas anteriormente en dichas granjas. Curiosamente, se ha descrito que las regiones más varia-
bles fueron nsp2 y ORF3-5, mientras que los segmentos más conservados eran nsp9 y nsp10. Este patrón es similar al observado en otras cepas comunes aisladas en el pasado. Probablemente, la mayor deriva genética de Rosalía podría explicarse por la suma de dos factores. Por un lado, su mayor capacidad de replicación, lo cual explicaría las altas cargas virales y las viremias largas, y por otro, la situación epidemiológica concreta; esto es, la entrada de una cepa nueva muy diferente a las ya presentes en la población, por lo que los cerdos pueden considerarse como prácticamente vírgenes desde el punto de vista inmune frente a dicha cepa. Esta situación explicaría su rápida diseminación. En definitiva, cuantas más infecciones, más sucesos de replicación y, por lo tanto, mayor probabilidad de que aumente la deriva genética.
Otra causa que explicaría la variabilidad genética de esta cepa es la recombinación. Su rápida diseminación, alta cargas virales y viremias largas aumentan la probabi-
 Figura 2. Ejemplos de secuenciación de la ORF5. Errores de interpretación debido a recombinaciones.
Ejemplo 1. ORF5 recombinante
Ejemplo 2. Cepa recombinante con ORF5 de una solo cepa parental
Figura 2. Ejemplos de secuenciación de la ORF5. Errores de interpretación debido a recombinaciones.
Ejemplo 1. ORF5 recombinante
Ejemplo 2. Cepa recombinante con ORF5 de una solo cepa parental
Israel Hervas Bengochea/shutterstock.com 14 ■ SUIS Nº 195 Marzo 2023 ARTÍCULOS
Tabla. Parámetros productivos antes y durante los brotes de PRRS causados por la cepa virulenta descrita a principios de 2020 (Martín-Valls y col., 2023). Valor medio (valor máximo alcanzado). En rojo, valores significativamente superiores (P < 0,05).
Posibles medidas a adoptar frente a Rosalía:
■ Maximizar la bioseguridad externa a todos los niveles para evitar la entrada. Las granjas con peor puntuación en las encuestas de bioseguridad han demostrado tener una mayor probabilidad de infectarse.
■ Una vez infectada la granja, el manejo en bandas que permita hacer vacíos sanitarios puede acortar la duración del brote.
■ Minimizar el impacto y la prevalencia de las infecciones secundarias.
■ Revisar que los protocolos de vacunación de las cerdas y del reemplazo son los adecuados.
lidad de encuentro con otras cepas en un mismo animal, y, por tanto, la probabilidad de que existan recombinaciones. De hecho, durante los brotes analizados en el estudio anteriormente mencionado, se detectaron dos eventos nuevos de recombinación. Así, se estima que de los aislados secuenciados completamente hasta la
fecha, un porcentaje sustancial (> 15 %, en algunos casos podría alcanzar el 50 %) son virus que han recombinado con cepas ya presentes. Obviamente, ante esta situación, y tal y como ya se ha discutido, si solo secuenciamos la ORF5 se estarían clasificando erróneamente un número importante de aislados.
Tal y como se ha discutido en el presente artículo, el impacto de esta nueva cepa puede ser variable, pero en general muy elevado. Parece que dicho impacto ha variado con el tiempo, siendo en los primeros casos devastador, pero de corta duración, para más tarde tener un impacto medio pero sostenido en el tiempo. Independientemente del escenario actual, teniendo en cuenta que se ha demostrado en situaciones muy diversas (cepas virulentas, convencionales, brote clínico, positividad estable sin clínica aparente, etc.) que el impacto económico de esta enfermedad es elevado, cualquier medida que evite, disminuya o retrase la posibilidad de infección y sus consecuencias debe encararse con decisión. Los datos expuestos deben servirnos como palanca a la hora de tomar decisiones y afrontar de forma categórica las medidas necesarias para el control de esta enfermedad, desde la granja hasta el conjunto del sector.
BIBLIOGRAFÍA
• Baliellas. https://www.avparagon.com/docs/jornadas2022/PRRS-Jordi-Baliellas.pdf (2022).
• Canelli y col. Vet Microbiol (2017).
• Díaz y col. SUIS (2017).
• Eclercy y col. Viruses (2019).
• Ferrari y col. Vet Microbiol (2018).
• FristiKová y col. Anaporc (2022).
• Frydas y col. Vet Microbiol (2016).
• Holtkamp y col. J Swine Health Prod (2013).
• Kvisgaard y col. Transbound Emerg Dis (2020).
• Kim y col. Animals (Basel) (2022).
• Li y col. Emerg Infect Dis (2009).
• Martín-Valls y col. J Virol (2014).
• Martín-Valls y col. Mic Resour Announc (2022).
• Martín-Valls y col. PHM (2023).
• Martínez-Lobo y col. Vet Microbiol (2011).
• Nathues y col. Prev Vet Med (2017).
• Nieuwenhuis y col. Vet Rec (2012).
• Pamornchainavakul y col. Front Vet Sci (2022).
• Stadejek y col. Vet Microbiol (2013).
Antes
Granja 1 Abortos 1,0 % 28,7 % (71,0 %) 17 Nacidos muertos 6,8 % 9,4 % (27,0 %) 17 Momificados 0,6 % 1,8 % (9,6 %) 16 Mortalidad cerdas 1,0 % 6,5 % (25,0 %) 39 Mortalidad maternidades 10,9 % 7,3 % (10,6 %) 0 Granja 2 Abortos 1,5 % 11,1 % (35,4 %) 42 Nacidos muertos 8,3 % 13,0 % (16,7 %) 37 Momificados 2,9 % 6,8 % (28,5 %) 40 Mortalidad cerdas 1,2 % 3,7 % (7,9 %) 11 Mortalidad maternidades 13,5 % 15,0 % (31,3 %) > 42 Granja 3 Abortos 0,7 % 5,9 % (10,4 %) 12 Nacidos muertos 1,6 % 10,7 % (37,1 %) > 39 Momificados 1,7 % 2,6 % (11,5 %) > 39 Mortalidad cerdas 0,7 % 2,5 % (5,2 %) 39 Mortalidad maternidades 12,2 % 16,1 % (38,3 %) > 39 1Tiempo necesario para recuperar los valores previos al brote.
del brote Durante el brote Semanas retorno1
SUIS Nº 195 Marzo 2023 ■ 15 ARTÍCULOS
Mejora de la producción basada en la implantación del manejo en bandas a tres semanas en Ibérico (I)
Abstract Resumen
En este artículo se muestra un trabajo de planificación de la producción en explotaciones porcinas de cerdo Ibérico con sistemas de manejo en bandas semanales, para implantar un sistema de manejo en bandas a tres semanas, persiguiendo conseguir las mejoras que este aporta principalmente en los pilares de la sanidad, planificación productiva, y recursos humanos, valorando las repercusiones en productividad y rentabilidad económica. Se analizan datos de tres explotaciones de cerdo Ibérico, en dos de ellas se produjeron estos cambios entre 2017-2018 (granjas 1 y 2), y se sigue el ejemplo de una pirámide productiva en la que se ha instaurado en 2021 (granja 3), los datos recopilados de estas granjas son promediados al censo de la granja 3. En sanidad porcina se analiza la evolución patológica a virus del Síndrome Reproductivo Porcino (PRRS) y Circovirus porcino serotipo 2 (PCV2), siendo estas las patologías más importantes que intervienen en las mismas. Se realiza un estudio comparativo de ambos tipos de planificación productiva, valorando las fortalezas y debilidades que resultan de manejar bandas a una semana frente a 3 semanas. En lo referente a los recursos humanos se examina las consecuencias ante el nuevo escenario de la producción porcina y su repercusión con la normativa laboral española. Sobre la base de los parámetros zootécnicos e inputs económicos se evalúan los costes de producción para determinar la rentabilidad en ambos sistemas.
Palabras clave: Bandas, mejora, productividad, rentabilidad.
Improving production in Iberian pig with three-week band management
This article shows a production planning work in Iberian pig farms with weekly band management systems, changing to a three-week band management system, in order to improve health, productive planning, and human resources, assessing the repercussions on productivity and economic profitability. Data from three Iberian pig farms are analysed. These changes occurred between 2017-2018 in two of these farms (farms 1 and 2), and the example of a productive pyramid is shown following a model established in 2021 (farm 3); the data collected from these farms are averaged to the census of farm 3. In swine health, the pathological evolution of Porcine Reproductive Syndrome Virus (PRRS) and Porcine Circovirus serotype 2 (PCV2) is analysed, because they are the most important involved diseases. A comparative study of both types of productive planning is carried out, assessing the strengths and weaknesses that result from managing bands of one week versus three weeks. Regarding human resources, the consequences of the new scenario of pig production and its repercussion with the Spanish labour regulations are examined. Based on zootechnical parameters and economic inputs, production costs are evaluated to determine profitability in both systems.
Keywords: Bands, improvement, productivity, profitability.
EL CERDO IBÉRICO: CONTEXTO ACTUAL
El sector del cerdo Ibérico ha experimentado un extraordinario crecimiento en la producción que ha tenido como resultado la implantación de sistemas intensivos, al igual que lo ocurrido con razas precoces que fueron establecidas a partir de la primera mitad del siglo XX. En el caso del cerdo Ibérico, se aplican tanto en reproductores como en animales en fases de recría hasta 20-23 kg peso vivo (2 @ PV) y la etapa de
engorde en sistemas principalmente en régimen de intensificación en naves, quedando reducida la producción extensiva al aire libre, así como el procedimiento tradicional de explotación en base al aprovechamiento de los recursos naturales de la dehesa. Por tanto, el sistema de granjas se desarrolla principalmente con construcciones especializadas para producción porcina, sin diferencia de raza Ibérica o razas precoces. Las modalidades de producción del cerdo Ibérico se regulan por el Real Decreto 4/2014,
por el que se aprueba la norma de calidad del cerdo Ibérico. Por su parte, las explotaciones porcinas en general están sujetas principalmente a normativas de bienestar animal, Real Decreto 1135/2002 de protección de cerdos, y de construcción y producción porcina, Real Decreto 306/2020, por el que se establecen normas básicas de ordenación de las granjas porcinas. Al igual que en razas precoces, la producción del cerdo Ibérico se está concentrando en grandes empresas integradas en
Juan Luis Criado Rius, Juan Luis Criado Rodríguez y Silvia Astola Fonseca
Contacto con los autores. Juan Luis Criado Rius, jlcriador@gmail.com.
16 ■ SUIS Nº 195 Marzo 2023 ARTÍCULOS
importantes grupos cárnicos, en los que priman los altos rendimientos productivos, contando con una elevada tecnificación y logrando incrementos significativos en el tamaño de la camada, a lo que contribuye también los avances en selección genética. Encontramos de esta manera granjas que superan los 20 lechones destetados por cerda y año (base de datos BDPorc), conjuntamente con mejoras de la nutrición, instalaciones, la salud de la piara y el manejo (Aeceriber, 2013).
El manejo en bandas a 3 semanas que habitualmente se había establecido en granjas de cerdos precoces con menos de 500 cerdas reproductoras, actualmente se practica en más del 80 % de las granjas de cerdo Ibérico. Entre sus ventajas se encuentra el poder destetar lechones con una edad mínima de 28 días, teniendo en cuenta el peso inferior al nacimiento en esta raza que condiciona la viabilidad en las siguientes fases de desarrollo. Existe además un componente añadido como es el flujo comercial de grandes lotes de animales para cebar. Este sistema se perfila como una de las principales herramientas con las que hacer frente a la situación actual de control de enfermedades y competitividad, ya que entre otras ventajas se consiguen lotes homogéneos de gran número de animales para llenados completos de unidades de engorde (Porciplanet, 2020). Se pretende así poder trabajar con lotes de animales en un mismo estadio fisiológico o la misma edad, en un mismo periodo de tiempo, para agrupar los trabajos y aplicar el concepto de todo dentro/todo fuera de forma efectiva. En cuanto a recursos humanos, las granjas porcinas con manejo en bandas a tres
semanas se caracterizan por facilitar las circunstancias que conllevan a una mejora de las condiciones de trabajo, considerando específicamente la nueva regulación horaria y de descansos que establece la normativa laboral en vigor (Real Decreto-ley 32/2021). El manejo en bandas a tres semanas permite optimizar mejor, principalmente en granjas de madres (sitio 1), los días de descanso en fines de semana, al ejecutarse en semanas diferentes las fases de cubrición, partos y destetes.
OBJETIVOS
Este trabajo está basado en una amplia consulta de datos de diferentes explotaciones porcinas, donde se pone de manifiesto las ventajas que aporta para grandes estructuras porcinas la planificación productiva en función del manejo en bandas a tres semanas, en contraposición al manejo clásico en bandas semanales, persiguiendo un óptimo rendimiento tanto en índices zoosanitarios, como en costes económicos, así como la optimización de los recursos humanos. El principal objetivo que tiene este estudio es analizar las principales debilidades que concurren en una pirámide productiva porcina estándar, para poder implantar las acciones correctoras que nos lleven a mejoras de la producción, aprovechando los recursos disponibles y sin que ello conlleve un gasto económico excesivo. Es por eso por lo que durante todo el trabajo se exponen por separado los diferentes factores que debemos estudiar para conseguir esos logros. Así mismo, en lo referente a la estructura del censo y necesidades de instalaciones se hace un análisis comparativo entre sistemas de explotación de cerdo Ibérico y
raza precoz de capa blanca, dimensionando comparativamente ambos sistemas.
MATERIAL Y MÉTODOS
El estudio se realiza sobre la estructura de una granja de cerdos Ibéricos en régimen intensivo de 980 cerdas productivas en ciclo cerrado (granja 3), que tiene como base genética cerdas de raza Ibérica que se finalizan con cerdo de raza Duroc. En 2021, esta granja ha cambiado su planificación productiva de manejo en bandas a 1 semana (MEB 1s) a manejo en bandas a 3 semanas (MEB 3s).
También se han analizado los datos productivos de dos granjas más con la misma base genética, que hicieron la misma conversión productiva en 2017 y 2018, siendo estas igualmente de ciclo cerrado, con un censo de cerdas productivas de 560 y 420 respectivamente, granja 1 y 2, todas asesoradas por la consultoría especializada en gestión porcina Pork Global Gestion SL Se han examinado los datos de estas tres explotaciones porcinas evaluando el antes y el después de ambas planificaciones productivas (MEB 1s vs MEB 3s), para lo cual se han estimado tanto los indicadores sanitarios como los ratios productivos y económicos, estudiando el periodo de un año antes de la conversión y un año después de la misma. Los datos obtenidos de estas tres granjas son extrapolados y promediados a la granja de 980 cerdas reproductoras productivas (granja 3), ya que al llevar las otras más tiempo con el sistema a 3 semanas, la valoración es más objetiva, siguiendo el ejemplo de otros trabajos realizados por diferentes autores (Salvador y cols., 2022). Determinados datos productivos han po-

SUIS Nº 195 Marzo 2023 ■ 17 ARTÍCULOS
dido ser sometidos a análisis estadístico y así valorar la significación estadística de los mismos. Para ello, se ha realizado un análisis de varianza del factor a estudiar, con un nivel de confianza del 95 %, y evaluar así su grado de dispersión con respecto a la media (test ANOVA), utilizando la prueba F como cociente de dos varianzas. La estadística F permite relacionar la igualdad de las medias obtenidas; de esta manera, los valores más altos representan mayor dispersión.
F = variación entre las medias de las muestras/variación dentro de las muestras
Según el equipo asesor de Pork Global Gestión, el estatus sanitario de las tres granjas analizadas coincide con escasas diferencias en la expresión de las patologías presentes. Estas granjas son positivas a los principales patógenos específicos del porcino, entre los que destacamos virus Síndrome Respiratorio Reproductivo Porcino, Circovirus porcino serotipo 2 y Mycoplasma hyopneumoniae. Este es el motivo de haber optado por las mismas y haber descartado otras. Ya en 2015, ante los planes de reducción y supresión de antimicrobianos, esta consultora apostó por reconvertir las granjas de reproductoras de MEB 1s a MEB 3s. En todas las explotaciones estudiadas se vacunan los reproductores frente a PRRS, con virus vivo atenuado, y los lechones en lactación frente a Mycoplasma hyopneumoniae y Circovirus porcino serotipo 2. Se ha realizado el estudio de dimensionamiento de la explotación de referencia (granja 3), procediendo a los cálculos necesarios de los requerimientos en instalaciones que precisan ambos sistemas, y haciendo una comparativa de los mismos para una granja de cerdo blanco con el objeto de tener también una referencia de las instalaciones requeridas para estas granjas. Se consideran las fortalezas y debilidades que aporta el MEB 3s, sobre parámetros de sanidad, recursos humanos, planificación del manejo o gestión de la explotación. En los aspectos sanitarios se toman como indicadores las patologías del Síndrome Respiratorio Reproductivo Porcino y Circovirosis Porcina (PCV2) al ser producidas por agentes primarios que propician la aparición y desarrollo de otras enfermedades concomitantes (Quesada, 2015), y por ser las que mayor impacto patoló-
gico y repercusión económica causan en producción porcina. Para evaluar la dinámica de infección y evolución patológica se examinan los resultados analíticos frente a ambas enfermedades que son realizados con frecuencia cuatrimestral. Con los controles analíticos y la monitorización de la mortalidad se evalúan los cambios en las coinfecciones provocada por virus PRRS y PCV2 mediante el estudio de la dinámica de infección, a través de la evolución de anticuerpos seroneutralizantes (ELISA) y determinación de la presencia viral (PCR cuantitativo). En este último caso se realizan pools de muestras unificando el material biológico, en este caso suero sanguíneo para 2 o 3 muestras de cada categoría, y así tener la certeza de que no ha habido interferencias con anticuerpos maternales y/o vacunales. Todo ello contrastado con la mortalidad de animales en cada fase, comparando la situación que se daba cuando estas granjas se planificaban en MEB 1s y posterior a la implantación del MEB 3s una vez transcurrido un año, estableciendo un tamaño de muestra que permita un nivel de confianza del 95 %. Por otra parte, se monitorizan los resultados productivos obtenidos, que están registrados en los programas informáticos de gestión de estas granjas, promediando los datos productivos obtenidos de las tres granjas en la granja 3 de referencia. Las granjas 2 y 3 utilizan el programa informático PigChamp® y la granja 1, el programa Isagri®. Para el análisis económico, se utilizan las herramientas de gestión de costes desarrolladas por Pork Global Gestión, evaluando los datos económicos principalmente de la granja 3, al no tener un acceso completo de esta información de las otras dos explotaciones, y contrastado a su vez con el análisis de gestión económica de SIP Consultors. Los parámetros productivos analizados son:
■ Tasa de parto. Se han monitorizado los datos medios de fecundidad por lotes de cubrición de cada granja, 52 para MEB 1s, y 18 para MEB 3s.
■ Lechones nacidos vivos/camada y destetados/camada. Se contabilizan al azar los lechones nacidos vivos de un total de 208 camadas de cada granja para MEB 1s, 4 por cada lote de parto, 218 para MEB 3s, 12 en cada lote de parto.
■ Peso al nacimiento y peso al destete. Se analiza el peso medio por camada de un total de 208 camadas para MEB 1s y
218 para MEB 3s. En este caso los datos examinados corresponden a la granja 3.
■ Peso de recrío. Se trata del peso de salida de esta fase en su paso a cebo. En las tres granjas se estudia el peso medio de cada lote obtenido en la pesada de los camiones de carga en su traslado a cebo, 52 lotes para MEB 1s, y 18 para MEB 3s.
■ Peso de cebo. En este caso se examina el peso medio del cerdo obtenido de la pesada del camión de salida con destino a sacrificio. Con los datos facilitados de las tres granjas se han contabilizado 160 cargas para MEB 1s y 188 para MEB 3s.
■ Tasa de mortalidad. Se analizan los porcentajes de mortalidad de cada granja, obtenidos por semana desde el nacimiento hasta salida a sacrificio, 4 en fase de lactación, 5 en fase de recrío, y hasta 40 semanas en fase de engorde.
RESULTADOS
En esta entrega se presentan los resultados obtenidos en cuanto al dimensionamiento de las explotaciones. En la segunda entrega se añadirán los relativos a los recursos humanos, la repercusión sanitaria, los parámetros productivos y el análisis económico, junto con la discusión y las conclusiones.
Dimensionamiento
Para el estudio comparativo del manejo en bandas a MEB 1s frente a MEB 3s, se emplea como ejemplo una granja de 980 cerdas productivas, a partir de la que se obtiene el número de bandas y número de plazas (tablas 1 y 2).
Cálculo
bandas. Ciclo de la cerda (días) - Gestación 114 - Lactación 28 - Intervalo destete-cubrición 7 - Total 149 Nº MEB 1 semana 149/7 = 21 Nº MEB 3 semanas 149/21 = 7 Tabla 2. Número de plazas por banda. N.º de plazas/ banda: N° Cerdas productivas/ Nº de bandas 1 semana 980 / 21 ± 46 3 semanas 980 / 7 ± 140 18 ■ SUIS Nº 195 Marzo 2023 ARTÍCULOS
Tabla 1.
de las
Maternidad
Los aspectos a considerar son:
■ Adaptación al parto: 7 días.
■ Lactación: 28 días.
■ Limpieza-Desinfección-Vacío sanitario: 2-3 días.
■ Intervalo entre bandas: 7 o 21 días.
El número de bandas, salas o lotes resulta de dividir la suma de días correspondientes a la adaptación al parto, lactación, y limpieza/desinfección/vacío sanitario, entre el intervalo establecido entre bandas. Por su parte, el número de plazas se obtiene de multiplicar el número de cerdas de cada banda por el número de bandas en maternidad (tabla 3).
Con cinco salas de maternidad el MEB 1s obliga a destetar con 22-23 días medios de lactación o bien disponer de una sexta sala, mientras que en el MEB 3s permite hacerlo a 28-32 días obteniendo lechones con mayor peso y por lo tanto más viables.
Gestación
Condicionado por el Real decreto 1135/2002 sobre protección de cerdos, en la gestación se diferencian dos etapas, una de gestación cubrición-control donde se permite la estancia en boxes hasta 28 días poscubrición (punto 4, artículo 3), y otra de gestación confirmada donde las cerdas tienen que estar en libertad en corrales o parques comunales al menos hasta 1 semana antes del parto.
El cálculo de plazas necesarias depende de la fertilidad de la granja, sufriendo los fallos reproductivos principalmente en la primera fase hasta los 28 días de gestación, aproximadamente en un 85 %, y menor a un 15 % en el resto de la gestación, lo que nos lleva a incrementar proporcionalmente el número de plazas en función de la eficiencia reproductiva de la granja; por otra parte, aunque no esté contemplado en la normativa, las cerdas jóvenes de reposición son introducidas en jaulas de gestación para su adaptación y sincronización de celo, para posteriormente unirlas a la banda correspondiente de cerdas multíparas, siendo necesario para ello un
tratamiento hormonal (altrenogest) por un periodo de 17 días.
Gestación control
Los aspectos para considerar son:
■ Intervalo destete-cubrición: 7 días.
■ Ocupación poscubrición: 28 días.
■ Limpieza-Desinfección-Vacío sanitario: 2-7 días.
■ Cerdas con alteraciones en la fertilidad. En este apartado hay que tener en cuenta a las cerdas repetidoras cíclicas (repeticiones de celo de 21-28 días); las cerdas anoéstricas; las cerdas gestantes no adaptadas a grupos (agresivas) o enfermas (donde se incluyen las de un estado corporal muy deficiente), que pueden llegar a representar hasta un 5 % de la gestación control; y las cerdas jóvenes (nulíparas de reposición), dejando pasar un ciclo de adaptación, el cual se aprovecha para su sincronización de celos, representan el 17-20 % de la banda. El número de salas o lotes resultante se obtiene de dividir la suma de días correspondientes al intervalo destete-cubrición, gestación control y limpieza-desinfecciónvacío sanitario, entre el intervalo establecido entre bandas (tabla 4).
Teniendo en cuenta las consideraciones descritas, el número de plazas resultaría de multiplicar el número de bandas por la suma del número de cerdas destetadas multíparas a cubrición + cerdas repetidoras + cerdas anoéstricas + cerdas agresivas y enfermas + jóvenes de reposición (reposición 16 % + 2 % infertilidades nulíparas = 18 %).
Siguiendo el ejemplo de la granja de 980 cerdas productivas, y teniendo en cuenta un equilibrio reposición desvieje de un 40 % efectivo, serían 23 cerdas/MEB 3s, y de 8 cerdas/MEB 1s, que salen y entran en cada banda, tasa de repeticiones a celo del 10 %, tasa de anoéstricas 2 %, porcentaje de cerdas agresoras y enfermas 5 %, porcentaje total de cerdas jóvenes de reposición 18 % (tabla 4).
En MEB 1s, al tener 5 lotes en gestación control estamos limitados a un solo día de
limpieza, desinfección y vacío sanitario, el de traslado; sin embargo, en el MEB 3s teniendo solo 2 lotes hay más días para realizar esta tarea.
En cuanto al número de plazas, si implementamos las cerdas de desvieje (16 % sobre cerdas productivas por banda), con una estancia máxima de 42 días, resultarían ±38 plazas más para MEB 1s, total 318, y de ±44 plazas para MEB 3s, total 378. En ocasiones, se suelen incluir en gestación control, aunque quedarían fuera del marco legal.
Gestación confirmada
Representada por cerdas en libertad, alojadas en grupos, lo que dificulta su control individual. De cualquier manera, a excepción de incidencias de patologías generalmente infecciosas que afectan gravemente a la fecundidad, en esta fase de gestación impera un gran equilibrio hormonal, proporcionado por el ovario y la placenta, por lo que las pérdidas de gestación se sitúan en tasas inferiores al 2 %. El cálculo de salas o lotes de cerdas resulta de restar a los días de duración de la gestación, los días de ocupación en gestación control y los días de adaptación al parto con estancia en la maternidad, todo ello dividido entre el intervalo establecido (tabla 5).
El número de plazas por su parte, según el mismo ejemplo de 46 para cerdas productivas en MEB 1s, y 140 MEB 3s, teniendo en cuenta un 1 % en pérdidas de gestación, más baja y eliminación de cerdas del 2 % por banda, se obtendría de multiplicar las bandas por la suma (♀/prod./banda + %♀ pérdidas gestación + %♀ bajaseliminadas) (tabla 5).
Es en esta fase donde debemos contemplar los alojamientos de las cerdas de desvieje/desecho (16 %/banda), por lo que precisaríamos para MEB 1s (equivalente a 6 lotes) 38 plazas, por lo que resultarían 528, y para MEB 3s 44 plazas extras (equivalente a 2 lotes), que añadidas a las anteriores suman un total de
479.
1s
3s Salas de parto 5 2 Plazas/sala 230 280
Tabla 3. Número de maternidades y plazas.
Bandas/Plazas MEB
MEB
MEB 1s
3s Bandas 5 2 Plazas 280 334
Tabla 4. Cálculo del número de bandas y número de plazas en gestación control.
Bandas/Plazas
MEB
1s
3s: Bandas 10 3 Plazas 490 435 SUIS Nº 195 Marzo 2023 ■ 19 ARTÍCULOS
Tabla 5. Cálculo de bandas y plazas en gestación confirmada.
Bandas/Plazas MEB
MEB
Transición
En esta etapa se alojarán los lechones en fase de recría, a partir del destete y durante un periodo de 35-40 días, generalmente para alcanzar un peso de 20-23 kg, edad media de 65 días (dato utilizado en todos los cálculos del cebo). Debemos hacer la consideración que en el caso del Ibérico estas instalaciones se suelen programar para una permanencia de 21 días más, estancia de 3 lotes y así obtener pesos mayores de 28-32 kg.
El número de salas necesarias se obtiene de dividir la suma de días de ocupación de la sala, más días de limpieza/desinfección/ vacío sanitario (2-4 días), total ± 42 días, entre el intervalo entre bandas (tabla 6). Por su parte, el número de plazas a dimensionar se obtiene de multiplicar el número de bandas por el número de lechones destetado. Va a depender de la prolificidad de la granja, en razas precoces actualmente se emplean líneas genéticas hiperprolíficas, con medias de 1517 lechones nacidos vivos por camada (media NV = 16), destetándose alrededor de 13-15 lechones (media LD = 13,5); en el caso de la raza Ibérica, estos datos se convierten en 7-9 lechones nacidos vivos (media NV= 8), y 6-8 destetados (media LD = 7) (tabla 6).
Engorde (crecimiento-cebo)
Cerdo blanco
El peso medio de cerdo blanco magro a sacrificio está en 105 kg. La edad para conseguirlo va a depender de la línea genética de que se trate, donde influye en gran medida el macho finalizador. En la actualidad, se opta mayoritariamente por líneas de mucho crecimiento, en detrimen-
to de otras donde se prima más la calidad de la carne. Por otro lado, estaría la optimización de la alimentación y finalmente, como condición principal, el estatus sanitario. En condiciones favorables de estos tres parámetros, genética, alimentación y salud, la edad media a sacrifico se consigue con 170 días, con lo que estarán en fase de engorde 105 días. El número de salas (lotes) en cebadero lo calcularemos igual que en la recría, dividiendo el tiempo de permanencia en cebo más el tiempo máximo de desalojo del cebadero (media de 15 días) y vacío sanitario (7 días) entre el intervalo entre bandas. El número de plazas resultaría de multiplicar el número de bandas por el número de lechones que pasan de recría a cebo, es decir número de lechones destetados menos bajas en transición (2 % en sistemas de alta salud), y lechones de saldo (animales retrasados sin valor completo, 1,5 %).

Cerdo Ibérico
En este caso tendremos en cuenta las modalidades de engorde que se llevan a cabo en esta estirpe racial, como son “cebo” (intensivo) y “cebo campo” (extensivo), y que contempla el Real Decreto 4/2014 sobre norma de calidad para la carne, el jamón, la paleta y la caña de lomo ibéri-
Tabla 7. Cálculo del número de lotes y número de plazas en cebo.
Nº salas (Días estancia + (Desalojo + Vacío sanitario))/intervalo (días)
Nº
Nº salas: Días estancia + Vacío sanitario/ Intervalo (días)
Nº plazas: (Lechones destetados/banda) × Nº salas
Cerdo blanco/cerdo Ibérico
Nº salas MEB 1s 6 MEB 3s 2
Cerdo blanco
Nº plazas MEB 1s 3.726 MEB 3s 3.780
Cerdo Ibérico
Nº plazas MEB 1s 1.932 MEB 3s 1.960
(Nº lechones que pasan a cebo) × Nº lotes Cerdo blanco
co, y la modalidad de comercialización de “cebo intensivo fuera de la citada norma de calidad”. Según la información recabada de la asociación interprofesional del cerdo Ibérico (ASICI), un 20 % de los cerdos Ibéricos cebados se sacrifican al margen de la norma de calidad. Sobre estos escenarios debemos hacer las siguientes consideraciones en función a la edad mínima de sacrificio:
■ Cebo: 10 meses.
■ Cebo campo: 12 meses.
■ Comercializados fuera de la norma de calidad: edad estándar de sacrificio 8 meses (tiempo necesario para adquirir el peso mínimo comercial de 150 kg PV). El periodo de ocupación resulta de restar a la edad de salida (días) la edad de entrada en cebadero, sumando al resultado los días de desalojo, más vacío sanitario, dividiendo el resultado final entre el intervalo se obtiene el número de salas (tabla 7). Para calcular el número de plazas al igual que en cerdo blanco, multiplicamos el número de lotes, por el número de lechones que pasan de recría a cebo (tabla 7).
Tabla 6. Cálculo del número de lotes y número de plazas en transición.
plazas
Nº salas MEB 1s 18 MEB 3s 6 Nº plazas MEB 1s 10.764 MEB 3s 10.920 Cerdo Ibérico Cebo Nº salas MEB 1s 37 MEB 3s 12 Nº plazas MEB 1s 11.488 MEB 3s 11.340 Cebo Campo Nº salas MEB 1s 46 MEB 3s 15 Nº plazas MEB 1s 14.283 MEB 3s 14.175 Cebo Fuera Norma Calidad Nº salas MEB 1s 28 MEB 3s 9 Nº plazas MEB 1s 8.694 MEB 3s 8.505 20 ■ SUIS Nº 195 Marzo 2023 ARTÍCULOS

Los contajes, mejor con Poisson que con Gauss (II)
En el número anterior comenzamos una serie de artículos para utilizar la distribución de Poisson en nuestras granjas. Decíamos, a modo de recordatorio, que puede ser de gran utilidad para las variables que provienen de contajes, como puede ser el número de lechones muertos por parto, el número de abortos a la semana o el número de lechones nacidos por parto.
Las variables que provienen de contajes cumplen determinadas características como:
1Tests and Trials SLU
2Universidad de Lleida
3Universidad Rey Juan Carlos (Madrid)
■ Son valores discretos. Más concretamente son contajes de números enteros no negativos (no tienen decimales), como el número de abortos en una semana, el número de repeticiones en una banda de cubrición, el número de lechones muertos por parto.
■ Los sucesos que ocurren en un intervalo de tiempo determinado son independientes.
■ Estos contajes pueden ser expresados también como tasas, ya que la cantidad de veces que ocurre un evento dentro de un periodo de tiempo se puede expresar bien como un conteo sin procesar (ha habido 3 abortos hoy) o como una tasa (la tasa de abortos al día es de 3 abortos/ día).
También vimos que esta distribución nos puede ayudar a responder a preguntas sobre probabilidad como cuál es la probabilidad de que tenga 7 abortos a la semana si en mi granja tengo 3 abortos a la semana como media (ver Suis nº 194, enero/ febrero 2023).
En la tabla se compara la distribución de Poisson y la de Gauss o Normal para ver claramente cuándo tenemos que usar una o la otra.
Pero quizá la forma en la que podemos observar y aprender mejor qué hace la distribución de Poisson sobre una variable es con un ejemplo. Vamos a usar los lechones nacidos muertos en el parto en una granja junto a 3 variables descriptivas y un tratamiento para estudiar esta distribución.
El conjunto de datos que vamos a usar es una modificación del conjunto de datos “cell.txt” que
se usa con fines didácticos en R para estudiar la distribución de Poisson. El lector puede encontrar este archivo en nuestro blog https://www. testsandtrials.com/blog/ con el nombre de “data_ poisson.txt”.
Como siempre, iniciaremos R, con la instrucción library(Rcmdr) activaremos RCommander y yendo a Datos/Importar datos desde un archivo Excel y nombrando el conjunto de datos como “data”, el sistema nos llevará a elegir dónde tenemos almacenado el archivo de datos. Aceptaremos y ya tendremos el conjunto de datos importado.

Para ver qué datos tenemos en el archivo, iremos a Estadísticos/Resúmenes/Conjunto de datos numéricos y nos aparecerá la siguiente salida:
> summary(data) nac_muer
Nuestra hipótesis de trabajo es que las diferentes genéticas de cerdas (variable genética) que tenemos en nuestra granja influencian el número de lechones nacidos muertos (variable nac_muer). Para establecer esta hipótesis nuestro equipo técnico ha estudiado las diferentes teorías sobre los lechones nacidos muertos por parto y tras eliminar varias posibles causas, cree que en nuestro
Distribución de Poisson
Variables de contajes o tasas
Curva asimétrica hacia la derecha dependiendo de su media (lambda, λ)
Media = Varianza
Distribución de Gauss o Normal
Variables continuas
Curva en forma de campana centrada en la media
La media y la varianza son diferentes, pero la media y la moda son iguales
Alberto Morillo Alujas1, Daniel Villalba Mata2 y Emilio López Cano3
genética edad nave peso Min.: 0.000 F:376 1 a 2: 107 alta: 227 gorda: 167 1st Qu.: 0.000T:135 3 a 6: 136 baja: 284 muy gorda: 140 Median: 0.000 mas de 6: 268 normal: 204 Mean: 0.908 3rd Qu.: 1.000 Max.: 7.000
Tabla. Diferencias entre la distribución de Poisson y la distribución de Gauss o Normal.
22 ■ SUIS Nº 195 Marzo 2023 APLICACIONES ESTADÍSTICAS
caso la genética de las cerdas es la responsable de ello. Al ser un estudio observacional, se han recogido también otras variables que podrían influenciar el número de lechones nacidos muertos. En este caso, se ha elegido la paridad de las cerdas (variable edad), la nave donde han realizado la gestación (variable nave) y el estado corporal al parto de las cerdas (variable peso).
Debemos ver cómo están distribuidas las cerdas por genética en cuanto a edad, nave y peso para ver que la presencia de la dos genéticas esté equilibrada para las otras tres variables. Para ello crearemos unas tablas de doble entrada y realizaremos un test de Chi-Cuadrado que nos dirá si el número de cerdas en cada pareja de variables es homogéneo o no.

Si vamos a Estadísticos/Tablas de contingencia/ Tabla de doble entrada… nos aparecerá un panel donde elegiremos por ejemplo en primer lugar la genética y la edad. En la pestaña Estadísticos, activaremos la opción Porcentajes por filas, aceptaremos y obtendremos la siguiente salida:
Frequency table:
edad
genética 1 a 2 3 a 6 mas de 6
A 62 40 33
B 45 96 235
Pearson’s Chi-squared test
data: .Table
X-squared = 82.76, df = 2, p-value < 2.2e-16
Podemos ver que tenemos 62 cerdas de la genética A de 1 a 2 partos, 45 de la genética B del mismo rango de partos y así sucesivamente. El estadístico ChiCuadrado (X-squared) es igual a 82,76, con 2 grados de libertad y el valor p es muy inferior a 0,05, lo que nos informa de que el número de partos no está igualmente distribuido en las diferentes paridades. El lector puede llevar a cabo el mismo procedimiento con las variables nave y peso. Si evaluáramos el efecto de la genética sin tener en cuenta el resto de variables, podríamos estar cometiendo un error, y por tanto es necesario hacer un análisis conjunto. Podríamos realizar también un análisis gráfico mediante histogramas. Yendo a Gráficas/Histograma… eligiendo en Gráficas por grupos... genética y en las opciones elegimos porcentajes y obtendremos la figura 1.
Una vez estudiadas la tabla y la figura anteriores, pasaremos a realizar un análisis de regresión, pero con un modelo lineal generalizado (GLM, en su abreviación en inglés) cuya variable respuesta, en nuestro caso el número de lechones nacidos muertos sigue una distribución diferente a la normal o gaussiana del tal forma que la relación entre la variable respuesta y la predictora no es lineal. Así, los modelos de regresión de Poisson se usan para modelizar variables de contajes y tablas de contingencia. Para ello iremos a Estadísticos/Ajustes de modelos/Modelo lineal generalizado... y nos aparecerá una ventana como la de la figura 2, donde construiremos el modelo. Allí, elegiremos la variable nac_muer como variable respuesta y el resto de las variables como predictoras. En la parte inferior derecha, elegiremos la Familia poisson y en la Función de enlace elegiremos log (figura 3).
 Figura 1. Histograma de los lechones nacidos muertos por genética en porcentaje.
Figura 1. Histograma de los lechones nacidos muertos por genética en porcentaje.
SUIS Nº 195 Marzo 2023 ■ 23 APLICACIONES ESTADÍSTICAS
Figura 2. Elección del modelo lineal generalizado en RCommander
Aceptaremos y obtendremos la siguiente salida:
nificativas y no están influyendo en el número de nacidos muertos por lo que las eliminaremos del modelo y construiremos uno nuevo (figura 4) siguiendo la sistemática anterior, pero esta vez sin las variables edad y nave. Y obtendremos la siguiente salida:
= nac_muer ~ genetica + peso, family = poisson(log), data = data)

Vamos a fijarnos de momento en la tabla de datos que hemos marcado en cursiva y en concreto en la columna Pr(>|z|) donde se nos informa del valor p Podemos ver que la variable edad y nave no son sig-
En el próximo número interpretaremos todos estos datos y veremos todas las posibilidades que nos ofrece la distribución de Poisson.

Call: glm(formula = nac_muer ~ genetica + edad + nave + peso, family = poisson(log), data = data) Deviance Residuals: Min 1Q Median 3Q Max -2.4787 -1.2493 -0.7866 0.5244 3.6826 Coefficients: Estimate Std. Error z value Pr(>|z|) (Intercept) 1.122342 0.105018 10.687 < 2e-16 *** genetica[T.B] -1.305209 0.111522 -11.704 < 2e-16 *** edad[T.3 a 6] 0.003507 0.130616 0.027 0.978580 edad[T.mas de 6] 0.058954 0.123849 0.476 0.634063 nave[T.baja] -0.124044 0.109401 -1.134 0.256860 peso[T.muy gorda] -0.393412 0.112328 -3.502 0.000461*** peso[T.normal] -0.925295 0.117704 -7.861 3.8e-15 *** Signif. codes: 0 “***” 0.001 “**” 0.01 “*” 0.05 “.” 0.1 “·” 1 (Dispersion parameter for poisson family taken to be 1) Null deviance: 1052.95 on 510 degrees of freedom Residual deviance: 803.72 on 504 degrees of freedom AIC: 1331.4
Call:
Deviance Residuals: Min 1Q Median 3Q Max -2.4779 -1.2706 -0.7908 0.5627 3.6575 Coefficients: Estimate Std. Error z value Pr(>|z|) (Intercept) 1.12167 0.08284 13.540 < 2e-16 *** genetica[T.B] -1.33584 0.09398 -14.214 < 2e-16 *** peso[T.muy gorda] -0.40664 0.11116 -3.658 0.000254*** peso[T.normal] -0.94845 0.11498 -8.249 < 2e-16 *** Signif. codes: 0 “***” 0.001 “**” 0.01 “*” 0.05 “.” 0.1 “·” 1 (Dispersion parameter for poisson family taken to be 1) Null deviance: 1052.95 on 510 degrees of freedom Residual deviance: 805.14 on 507 degrees of freedom AIC: 1326.8
glm(formula
Figura 4. GLM sin las variables edad y nave.
24 ■ SUIS Nº 195 Marzo 2023
Figura 3. Construcción del modelo Poisson de nuestro ejemplo en RCommander
APLICACIONES ESTADÍSTICAS





STORE.GRUPOASIS.COM
GESTIÓN DE EXPLOTACIONES PORCINAS
1. Sostenibilidad en explotaciones porcinas
2. Logística y protocolos LDDD
3. Eficiencia reproductiva
4. Maternidad: del periparto al destete
Ángela Gallardo Marín1, Emilio José Ruiz Fernández2, Manuel Guerra Rico2, Verónica Romera Roldán3, Manuel Toledo Castillo4, Elena Goyena Salgado5, Jose Manuel Pinto Carrasco6
1Veterinaria producción y auditora interna, Agropecuaria Casas Nuevas.
2Veterinario de producción, Agropecuaria Casas Nuevas.
3Ambientóloga, responsable de medio ambiente y calidad, Agropecuaria Casas Nuevas.
4Veterinario jefe de producción, Agropecuaria Casas Nuevas.
5Veterinario de producción, Piensos Cartagena SL.
6Ingeniero Agrónomo, SAT Hnos Chico.
Logística y protocolos LDDD
La logística es un punto clave en la trasmisión de enfermedades y en la reducción del uso de antibióticos. Pero, además, es imprescindible la limpieza y desinfección de las instalaciones como tarea clave para el mantenimiento de la sanidad de las explotaciones.
GESTIÓN DE LA LOGÍSTICA
La logística se define como el conjunto de medios y métodos necesarios para llevar a cabo la organización de una empresa, o de un servicio, especialmente de distribución. En el tema que nos ocupa, hay que ligarlo a la bioseguridad interna de la empresa. Es necesario tomar una serie de medidas para que los vehículos no sean los portadores de patógenos de una explotación a otra. La idea es no introducir enfermedades de explotaciones externas a la empresa, y en caso de tener granjas positivas a alguna enfermedad, no diseminarla a otras explotaciones. ¿Cómo? Si conseguimos evitar la entrada de vehículos externos y no controlados tendremos una buena parte del objetivo conseguido. Para el segundo caso, el control y planificación de los vehículos propios es fundamental.
El objetivo de este apartado es transmitir una serie de pautas para que, organizando los movimientos necesarios (primalas, desvieje y lechones, tanto de 6 kg como de 20), no se propaguen las enfermedades entre las explotaciones de la misma empresa.
Zonificar las explotaciones
Consiste en dividir el global de las granjas, de forma geográfica, según su localización. La idea es llenar los cebaderos de una zona con los lechones procedentes de esa misma zona. Es decir, llenar los cebaderos más cercanos de una granja con lechones de esa misma granja. Así se reduce la distancia y el coste de este transporte y aumenta la bioseguridad de la zona porque no se introducen animales externos.
Regular los movimientos
Hay que organizar una pirámide de bioseguridad de las explotaciones que regulen los movimientos entre explotaciones. La base de esta pirámide debe ser el estado sanitario de las granjas de producción
(analíticas periódicas) y en el caso de los cebaderos, el estado sanitario lo marca la granja de donde proceden los lechones que han entrado. Los movimientos entre explotaciones serán de granjas limpias (mejor estado sanitario) a granjas sucias (peor estado). En ningún caso al revés. Además, cuando se ha estado trabajando en granja sucia, al día siguiente, la jaula debe parar. En caso de no ser posible, debe continuar trabajando en granjas con el mismo estado sanitario que el día anterior.
Medio de transporte propio
Lo ideal sería que cada granja tuviera su medio de transporte. De esta manera nos aseguramos de que ese vehículo no irá de una granja a otra. Cargaría sus lechones, los llevaría al cebadero, se lavaría, desinfectaría y hasta la siguiente semana no volvería a cargar. Pero esto es muy caro.
Como consejo, decir que siempre que el granjero necesite vehículo para mover sus lechones a su destete es mejor que el transporte sea interno, propio de la granja. Así nos aseguramos de que no se introduzca un vehículo externo en un núcleo cerrado.
Lavar y desinfectar
Después de cada porte se debe pasar por el lavadero para lavar y desinfectar (figura 1). Esto no solo es fundamental para la bioseguridad de la empresa, sino que es un requisito legal. Siempre es recomendable que este trabajo lo realice la misma persona, y es fundamental el monitoreo del mismo mediante muestreo con esponjas.
Monitorizar
Para el monitoreo recomendamos hacer semanalmente una serie de jaulas, que trabajen con animales limpios y animales enfermos. Hay que organizar bien el muestreo para que a lo largo de un mes se revisen todas las jaulas existentes. También es re-
CURSOS DE FORMACIÓN CONTINUADA 26 ■ SUIS Nº 195 Marzo 2023
comendable al cabo del mes, hacer un muestreo de todo el colectivo de los vehículos. En estos muestreos no hay que olvidar hacerlo en las botas de trabajo, alfombrillas e interior de la cabina del camión. En estos monitoreos, no solo se comprueba la limpieza de la jaula (figura 2), sino también, la eficacia del desinfectante.

Diferentes destinos
Hay que diferenciar los vehículos que cargan lechones de los que cargan el desvieje. Hay que tener en cuenta que el destino del desvieje es matadero o un centro de recogida, donde no tenemos un control del resto de vehículos y animales que entran allí. Estas cargas se deben hacer al principio de la semana (lunes o martes) y siempre con una jaula que el día de antes haya parado, y al día siguiente no cargue. Se recomienda, que en caso de tener que cargar en dos granjas para completar el porte, se

haga primero en una granja limpia, y la segunda sea una granja sucia.
Llenado de los cebaderos
El llenado de los cebaderos debe completarse lo antes posible (7 días entre la primera y última entrada), a ser posible con lechones del mismo origen (si hay mezcla, que sea del mismo estado sanitario). También hay que tener en cuenta:
■ Los días de vacío (entre 10 y 15).
■ La distancia del cebo a la granja de origen y al matadero de destino (reducir distancias lo máximo posible reduce costes).
■ Respetar los programas de calidad de cada cliente y la capacidad legal de las instalaciones.
PIRÁMIDE DE BIOSEGURIDAD
La pirámide de bioseguridad (figura 3) se elabora en función del estado sanitario que tienen las distintas granjas de madres y lechoneras, y en el caso de los cebos este viene marcado por el origen de los lechones con el que se llenan en cada una de las cebas. En los niveles más altos se sitúa el centro de inseminación, granjas de genética y las recrías, que están libres de cualquier enfermedad. Posteriormente están las granjas de producción libre de PRRS y Mycoplasma (negativas). Luego se colocan las granjas de producción que están contaminadas de PRRS y Mycoplasma, según su actividad (negativo o positivo) y evolución (estable o inestable). Y, por último, se ponen las que tienen disentería y/o diarrea epidémica.
Todo esto debe venir avalado por analíticas periódicas (cada 3 meses), de forma que consideramos una granja limpia cuando hay 3 analíticas consecutivas negativas. Y es el momento de subirla de nivel.
Figura 1. Túnel de lavado
SUIS Nº 195 Marzo 2023 ■ 27 CURSOS DE FORMACIÓN CONTINUADA
Figura2. Interior del remolque una vez limpio, desinfectado y secado.
En cuanto se detecta un problema en la granja, se analiza y se sitúa en el nivel que le corresponde. Tanto las enfermedades a analizar para generar los distintos niveles, como la periodicidad de las analíticas, son libres, cada empresa debe tener los suyos. Lo importante es que con esta pirámide tengamos clara la restricción de movimientos entre explotaciones, tanto para el movimiento de animales, como de pienso y de visitas de veterinarios y técnicos (figura 4).
Todas estas pautas van encaminadas a fomentar la sanidad de las explotaciones y por ende de la empresa. Lo fundamental de todas estas medidas es que, si tenemos un brote de alguna enfermedad, no la diseminemos por el resto de las explotaciones. Hay que ser consciente de que las pérdidas económicas aparejadas a una enfermedad son muy elevadas y de difícil solución.
GESTIÓN DEL CENTRO DE LAVADO Y DESINFECCIÓN
En cuanto al lavado y desinfección de los vehículos del transporte de ganado se debe hacer en un centro de desinfección autorizado. Por facilidad de las tareas y gestión del centro siempre es mejor tener a una persona, o varias, dedicada a estas tareas a que sea el chófer. Cada uno debe ser profesional en su trabajo.
Descripción
El centro de lavado debe contar con una serie de instalaciones y condiciones mínimas:
■ Cartel indicador en el acceso, donde se puede leer claramente que se trata de un centro de limpieza y desinfección de vehículos de transporte de animales.
■ Un único acceso de entrada y otro de salida de vehículos.
■ De la misma forma, deben estar bien diferenciadas la zona sucia de la limpia. Siempre hay que facilitar que la trayectoria de los vehículos sea de zona sucia a zona limpia.
■ El recinto está cerrado exteriormente y la superficie de este será cementada o asfaltada en toda el área que ocupe el centro.
■ Deben estar bien diferenciadas las operaciones de la zona sucia y de la zona limpia, procurándose un flujo de materiales y servicios en línea recta:
- En la zona sucia: se hace la primera limpieza en seco de serrín y excrementos (estiércol sólido). Posteriormente, se hace un lavado con abundante agua fría a presión para retirar toda la materia orgánica existente.
- En la zona limpia: se hace un lavado con agua caliente con detergente y desinfectante. Posteriormente se aplica una mano de desinfectante. Se lava el exterior del vehículo y se pasa por el arco de desinfección.
■ En los centros deben existir distintas áreas:
- Instalaciones de lavado específicas. En ellas se realizarán las operaciones de limpieza y desinfección de los vehículos. Deben estar techadas, abiertas y con suficiente iluminación tanto natural como artificial. También deben poseer el suficiente desnivel para permitir la recogida de los líquidos procedentes de la limpieza y desinfección de los vehículos.
- Instalaciones de almacenamiento de los residuos orgánicos sólidos y líquidos, así como de un sistema de gestión de los residuos que se generen en la limpieza del vehículo.
- Almacén para cama limpia techado.
- Espacio suficiente para la maniobra de los vehículos, así como aparcamiento para su secado.
- Vestuario y oficina, donde se rellena el certificado de desinfección y se guardan los precintos.
Centro de inseminación, granjas de genética y recrías
Granjas de producción libres de PRRS y Mycoplasma (negativas)
Granjas de producción contaminadas de PRRS y Mycoplasma, según su actividad y evolución
Granjas con disentería y/o diarrea epidémica
28 ■ SUIS Nº 195 Marzo 2023 CURSOS DE FORMACIÓN CONTINUADA
Figura 3. La pirámide de bioseguridad se elabora en función del estado sanitario.
- Almacén. Reservado para el material, herramientas, maquinaria, almacenamiento de productos químicos, zona de depósitos, bombas, caldera, hidrolimpiadoras, etc.
Metodología
La limpieza y desinfección constarán de las siguientes etapas:
1. Limpieza inicial en seco
Constituye una etapa esencial, ya que los altos niveles de microorganismos patógenos presentes y la suciedad, pueden reducir la eficacia de la limpieza y desinfección posteriores. Esta etapa incluye la retirada de todos los restos orgánicos visibles (excrementos, cama y otros desechos). Estos restos se acumulan en la zona de almacenamiento de los residuos orgánicos sólidos. Las maniobras de trabajo pueden incluir cepillos, raspadores y palas. Se empezará por el interior del camión, trabajando desde la superficie superior hacia la inferior, prestando especial atención a las áreas difíciles de limpiar, tales como puertas y paredes laterales. Se continuará con la parte externa de los vehículos, trabajando también desde la parte superior a la inferior.
2. Limpieza inicial con agua (prelavado)
El vehículo se lava con manguera y agua a presión suficiente para arrastrar los sólidos, que serán recogidos en una arqueta para su posterior evacuación y eliminación en la balsa de purín (almacenamiento de los residuos líquidos). La limpieza con agua debe realizarse siempre comenzando por el interior,
empezando por el punto más alto del vehículo y acabando por el más bajo. Prestar especial atención a las áreas difíciles de limpiar, tales como puertas de separación y paredes laterales. Abrir los separadores y limpiar bien las barras y recovecos. Continuar con la parte externa del camión, trabajando desde la parte superior a la inferior. No olvidar las rampas, el ascensor, el guardabarros, las llantas de las ruedas y el cajón de las botas.
3. Lavado con agua caliente
Después de realizar el prelavado, se procede al lavado con agua caliente. Hay que limpiar todo el vehículo con agua caliente a presión (entre 50 y 70 °C) y detergente con desinfectante; prestar atención a jaula, ascensor, ruedas, bajos, cajón de botas y carrocería. Comenzar por el interior del vehículo y terminar por la parte externa.
4. Desinfección
Rociar la zona habilitada para el transporte del ganado (interior) con desinfectante, comenzando por el punto más alto y terminando por el más bajo. El exterior del vehículo también se debe desinfectar, tanto carrocería como las ruedas, el guardabarros y las llantas. Con un arco de desinfección esta tarea es más fácil.

5. Precintado
En esta tarea se deja secar el remolque, se carga el serrín y se coloca el precinto del vehículo. En él debe figurar el número de registro oficial del centro y el número de precinto.
SUIS Nº 195 Marzo 2023 ■ 29 CURSOS DE FORMACIÓN CONTINUADA
Figura 4. Túnel de lavado y desinfección para cubas de pienso.
La realización de las operaciones de limpieza y desinfección de cada vehículo quedará justificada mediante la emisión del certificado de desinfección.
No hay que olvidar la limpieza de la cabina (alfombrillas, pedales, palanca de cambios y volante). Una vez limpio, se aplicará desinfectante en spray. Esta fase será responsabilidad del transportista. Al igual que el lavado de ropa de trabajo y botas. La ropa y calzado del transportista deberá cambiarse después de cada carga y descarga.
PROTOCOLOS DE LIMPIEZA Y DESINFECCIÓN
La limpieza y desinfección de las instalaciones son tareas clave para el mantenimiento de la sanidad de las explotaciones.
Si queremos mejorar la sanidad de nuestras explotaciones debemos tener claro que no todas las enfermedades infecciosas las podemos controlar mediante el uso de vacunas y que, actualmente, no podemos hacer un uso indiscriminado de los antibióticos. Por lo tanto, es necesario que la bioseguridad de nuestras granjas y el manejo de las instalaciones, y de los animales, sea excelente para evitar en la medida de lo posible la entrada (bioseguridad externa) y/o propagación de agentes patógenos (bioseguridad interna).
Para hacer frente a este reto debemos contar con protocolos de bioseguridad y manejo adecuados, sabiendo además que es la forma más rentable de controlar las enfermedades.
Cada vez que sale un lote de producción aplicamos medidas como la limpieza, la desinfección y el vacío sanitario con el fin de disminuir el grado de presión de infección que afectará al siguiente lote (figura 5). No hay que olvidar que los animales deben contar con un entorno limpio y confortable que les garantice su bienestar. Sabemos que la desinfección es imprescindible para inactivar a los agentes patógenos. También conocemos que esta no es eficaz si no hay una buena limpieza previa que retire toda la materia orgánica que inactiva el desinfectante empleado. Incluso sabemos que un buen vacío sanitario mejoraría mucho nuestra sanidad. Con respecto a este último punto, bien por las condiciones de
nuestras instalaciones (falta de plazas de maternidad, etc.), o bien por las pocas opciones que tenemos de modificar el manejo de los animales (que de alguna forma está ligado a lo anterior) nos quedamos en ocasiones con un aprobado. Sabemos que la teoría es una cosa y la práctica otra y que tenemos que trabajar con las granjas que tenemos, de forma que, la manera de subir nota será mejorando nuestros programas de limpieza y desinfección y adaptarlos a las condiciones de cada explotación (tabla).
La limpieza es tan importante que nos ayuda a eliminar el 90 % de los microorganismos (siempre que se realice de forma adecuada) y mejora la eficacia de los desinfectantes (FAD Prep, 2014).
Hay que revisar de forma periódica nuestros programas de limpieza, desinfección, desinsectación y desratización (LDDD), y, sobre todo, monitorizarlos para comprobar que se están realizando y que son eficaces. Para ello, y en el caso de la limpieza y desinfección, es de gran ayuda la toma de muestras, mediante gamuzas, de las diferentes superficies (paredes, tolvas, bebederos, placas térmicas, etc.) una vez lavadas y desinfectadas. Esto nos va a ayudar a conocer cuáles son nuestros puntos críticos en los que tendremos que hacer un especial esfuerzo.
Actualmente, no hay unos valores de referencia que nos indiquen el “grado” de desinfección correcto. Por eso tendremos que crear nuestra propia tabla de referencia que nos permita establecer un nivel a partir del cual siempre tendremos que mejorar. Cuando no sea así, tendremos que revisar el protocolo y, en caso de que se esté realizando de forma correcta, cambiar de desinfectante, teniendo en cuenta que hay una serie de patógenos que nunca deben aparecer.
La toma de muestras debe realizarse de forma cuidadosa para asegurarnos de que el material recogido corresponde al presente en la superficie a muestrear. Las gamuzas estériles se conservan refrigeradas hasta el momento de la toma de la muestra y su manipulación debe realizarse con guantes. Antes de acceder a la zona que queremos chequear, tendremos que ponernos calzas limpias. Para co-
6. Certificado o talón de desinfección
7. Limpieza de la cabina
En presencia de animales 106-109 gérmenes/cm2 Después de retirar la materia orgánica y lavar Desaparece el 80 % Después de una desinfección eficaz <10.000/cm2 Con una desinfección terminal Quedan 1.000/cm2 30 ■ SUIS Nº 195 Marzo 2023 CURSOS DE FORMACIÓN CONTINUADA
Presencia
de
microorganismos (Sofer France, 1994; Gil Berduque, 2006)
nocer cómo se está realizando la desinfección de nuestras instalaciones tenemos que tomar muestras de suelos, paredes, separadores, tolvas y bebederos eligiendo aquellas zonas de más difícil acceso, donde pensamos que el lavado y la desinfección pueden haber sido realizadas de una manera más superficial (figura 6).

Las superficies de muestreo serán de 10 cm². Una vez recogida la muestra, cada gamuza se introducirá en una bolsa limpia, preferiblemente con cierre Zip y se identificará de forma adecuada. Se mantendrá en refrigeración y se enviará al laboratorio antes de 24 horas.

Para cada una de las superficies de las que tomemos muestras tendremos que solicitar los recuentos de los siguientes microorganismos:
■ Aerobios totales
■ Enterobacterias
■ Coliformes totales
■ E. coli ß-glucuronidasa +
■ Estafilococcus aureus coagulasa +
■ Estreptococos fecales
Figura 5. Lavado y desinfección de la zona de cubrición entre dos lotes.
SUIS Nº 195 Marzo 2023 ■ 31 CURSOS DE FORMACIÓN CONTINUADA
Figura 6. Recogida de muestra con gamuzas.
¿Contaminación del medioambiente?
Con respecto a la contaminación del medioambiente de las instalaciones de las distintas fases de producción, no sabemos en qué medida es responsable del origen de una enfermedad, aunque sí conocemos que tiene un papel importante en la transmisión de infecciones. Por lo tanto, podría resultar interesante evaluarlo de forma periódica, ya que también puede ser un indicador de la eficacia de nuestros programas de desinfección. Para ello, emplearemos placas de cultivo con medios adecuados para el crecimiento de agentes bacterianos (figura 7). El método es sencillo, ya que solo es necesario dejar abiertas las placas de cultivo en el ambiente que queramos muestrear. Sin embargo, hay que tener cuidado en no exceder el tiempo de muestreo y evitar zonas con corrientes de aire porque pueden alterar los resultados. Una vez recogidas, se incuban en una estufa (el tiempo y la temperatura variarán en función del microorganismo) y posteriormente se hará una identificación y recuento. A partir de ahí, estableceremos nuestras propias tablas. Como en el caso de las gamuzas, no tenemos valores de referencia, así que deberemos tener en cuenta una serie de aspectos (tamaño de las salas, frecuencia de muestreo, etc.) para diseñar nuestro protocolo de control microbiológico medioambiental, y a partir de los primeros resultados, ir sacando conclusiones que nos permitan mejorar la calidad del aire.

PRINCIPALES PAUTAS PARA UNA CORRECTA LIMPIEZA Y DESINFECCIÓN
En primer lugar, tenemos que desmontar tolvas, separadores, etc. para poder limpiarlos por separado y asegurarnos, al mismo tiempo, de que las zonas donde apoyan quedan libres para su correcta limpieza. En la sala de maternidad encontraremos alguna dificultad añadida por el hecho de que algunas estructuras no las podemos desmontar por completo o se pueden estropear (jaulas, placas calefactoras, etc.).
Seguidamente, debemos retirar toda la materia sólida que esté adherida a las superficies. Es conveniente dejar la nave a remojo unas horas antes de aplicar un detergente en espuma en paredes, techos y suelos. Si bien algunos estudios demuestran que esta medida no mejora los recuentos bacterianos, sí que reduce el tiempo de lavado total. Conviene conocer cómo es nuestra agua (pH, dureza) para elegir de forma correcta el detergente. Es importante dejar que la espuma actúe durante unos 20 minutos para que pueda penetrar y despegar la capa grasa. Si la retiramos mucho después, habrá cristalizado y será mucho más difícil hacerlo. La aplicación de la espuma en las paredes se hace de abajo hacia arriba y la retirada en sentido contrario para arrastrar toda la suciedad hacia el suelo, que es la siguiente zona para limpiar. El siguiente paso será realizar un aclarado con agua asegurando que se retira toda la espuma.
Por último, haremos la desinfección. Muchos desinfectantes actúan a temperatura ambiente (2022 °C) y siempre hay que seguir las normas de seguridad del fabricante. Tenemos que emplear las dosis que aconseja el fabricante, ya que dosis superiores no aseguran una mayor desinfección y con dosis menores podemos crear resistencias al principio activo empleado.
No hay que olvidar las tuberías
Para la limpieza y desinfección de las tuberías, con la nave vacía, aplicaremos un producto específico a altas dosis, como el dióxido de cloro. Sabremos si el producto se ha distribuido por todas las tuberías de la nave, si al abrir el final de la red, el agua sale con el color característico del producto empleado. La misma comprobación la realizaremos en los
Limpieza de los depósitos del agua
Es conveniente limpiarlos al menos una vez al año siguiendo el siguiente procedimiento:
1. Vaciarlos por completo.
2. Limpiarlos con un cepillo duro y lejía (pura, sin aditivos) o con cualquier otro desinfectante apto para la desinfección del agua.
3. Por último, enjuagarlos con agua abundante antes de volverlo a llenar.
32 ■ SUIS Nº 195 Marzo 2023 CURSOS DE FORMACIÓN CONTINUADA
Figura 7. Cultivo en placa de Petri.
chupetes. Es necesario dejar que el producto actúe durante 24 horas y asegurarnos de realizar un buen enjuague pasado este tiempo.
Para monitorizar si la limpieza es correcta, basta con medir los niveles de cloro libre en el punto de entrada del agua y el punto de salida más distante. Bajos niveles de cloro libre nos indican que sigue habiendo contaminación por biofilm (conjunto de microorganismos que crecen sobre una superficie en contacto con el agua) en las tuberías, y que, por lo tanto, el proceso no se ha realizado correctamente.
Una limpieza y desinfección incorrecta pueden implicar que el biofilm que va apareciendo dentro de las tuberías no se elimine por completo. Esto puede traer, entre otras consecuencias, la disminución de la eficacia de la medicación añadida al agua o la obstrucción de tuberías y chupetes. Además, esa red de microorganismos formada protege a los patógenos frente a la acción de desinfectantes utilizados habitualmente (como el cloro), debido a la película que forman por la liberación de mucopolisacáridos.
Atención a los silos y almacenes de pienso
Los silos y almacenes de pienso también hay que limpiarlos de forma rutinaria, ya que los piensos pueden contaminarse con diferentes microorganismos patógenos (enterobacterias y hongos princi-
Formación del personal
Para que estos protocolos funcionen debemos tener un personal bien formado en las granjas, el cual debe ser conocedor de la importancia de estos procedimientos y conocer el manejo y la aplicación de los distintos productos empleados.
Una forma de que vean el alcance de su trabajo es hacerles partícipes de la monitorización. De esta forma, conseguiremos que la limpieza y la desinfección de nuestras instalaciones sean mejores.
Los protocolos de limpieza deben figurar claramente descritos en nuestros SIGE y tenemos que entrenar al personal en estas tareas, ya que son una de las claves para mantener la sanidad de las explotaciones.
palmente). Los silos se deben vaciar y limpiar, despegando los restos de pienso que puedan quedar adheridos a ellos, para después realizar una desinfección con los diferentes productos que existen en el mercado (sprays, velas, etc.).

CURSOS DE FORMACIÓN CONTINUADA


Ensayo de una nueva vacuna frente a PRRS elaborada a partir de plantas
Una vacuna de subunidades que contenga las dos proteínas más abundantes de la envoltura viral del virus del síndrome respiratorio y reproductor porcino (PRRS), la proteína de matriz (M) y la proteína glicosilada 5 (GP5), puede inducir una respuesta inmunitaria neutralizante frente al virus, proporcionando una defensa eficaz contra la enfermedad. Sin embargo, estas proteínas son difíciles de expresar.
En este trabajo, los investigadores intentaron que porciones antigénicas de las proteínas M y GP5 se mostrasen en la superficie de partículas del virus del mosaico del tabaco. Una proteína modificada de la cubierta del virus del mosaico del tabaco (TMVc) se expresó transitoriamente en hojas de Nicotiana benthamiana (una planta utilizada para producir anticuerpos monoclonales) y fue dirigida a tres compartimentos subcelulares a lo largo de la vía secretora para introducir patrones de glicosilación, importantes para la inmunogenicidad del epítopo M-GP5. Los investigadores constataron que los niveles de acumulación en el apoplasto eran similares que en el retículo endoplasmático y la vacuola.
Debido a que los glicanos presentes en las proteínas apoplásticas de las plantas son los más cercanos a los presentes en las proteínas del PRRSV, se dirigió una construcción de fusión TMVc-M-GP5 al apoplasto y se obtuvo a razón de más de 0,5 mg/g de peso fresco de la planta.
Las partículas pseudovirales de TMVc se autoensamblaron en células vegetales y mostraron en la superficie el epítopo M-GP5, tal y como se pudo comprobar mediante la visualización por microscopía electrónica de transmisión y tinción inmunogold.
Estos prometedores hallazgos pueden sentar las bases para futuros estudios de inmunogenicidad y de inmunidad protectora en animales, de cara a evaluar la eficacia de esta vacuna que es candidata para convertirse en medida de control del PRRS.
Plant production of a virus-like particle-based vaccine candidate against porcine reproductive and respiratory syndrome. Jordan T. VanderBurgt, Ondre Harper, Christopher P. Garnham, Susanne E. Kohalmi y Rima Menassa. Front. Plant Sci., enero 2023. https://doi.org/10.3389/fpls.2023.1044675
El comentario
El objetivo principal de este estudio fue valorar si era posible producir en plantas una partícula pseudoviral (virus like particle) que expresara proteínas asociadas al desarrollo de una inmunidad adquirida protectiva frente al virus del síndrome respiratorio y reproductivo porcino (PRRSV). El virus PRRS es un virus ARN que presenta una enorme variabilidad debido a su alta tasa de mutación, propia del virus, y a la elevada prevalencia presente en las poblaciones porcinas. En la actualidad, las únicas vacunas registradas para el control de esta enfermedad, a nivel europeo, están basadas en el virus completo inactivado o en virus vivo atenuado. Se conoce bastante bien que la protección conferida es mucho mejor si los virus campo son homólogos que sin heterólogos respecto a la cepa vacunal. A efectos prácticos es muy difí-
cil predecir la eficacia que conferirán las vacunas para cada caso clínico en particular, ya que no se conoce con precisión los puntos críticos asociados con protección para este virus. Por otra parte, las vacunas existentes no permiten diferenciar animales infectados naturalmente de animales vacunados. Este hecho supone, sin duda, una enorme limitación para el control de esta enfermedad.
Por tanto, es lógico que muchos grupos de investigación estén desarrollando nuevas vacunas basadas en aproximaciones diferentes a las que existen en la actualidad, pensando en obtener una vacuna DIVA (que diferencie animales infectados naturalmente de vacunados) y que confiera una protección aceptable frente a un número muy diferente de cepas de este virus. En este trabajo, se describe una aproximación vacunal nueva basada en la generación de una partícula pseudoviral producida en plantas.
Fraile Sauce Profesor Agregado

En el estudio queda claro que esta aproximación está en una fase de desarrollo muy inicial y que es necesario desarrollar estudios de inmunogenicidad y de protección frente a un desafío para confirmar si esta opción es una aproximación que pueda llegar a ser utilizada a nivel de campo. Sin duda, este tipo de investigaciones debería priorizarse porque el control de esta enfermedad del porcino es crítico para garantizar la sostenibilidad de este sector a largo plazo.

36 ■ SUIS Nº 195 Marzo 2023 ÚLTIMAS INVESTIGACIONES
■ Lorenzo José
Departamento de Producción Animal Universidad de Lleida, España
Rafael Astorga Márquez, Santiago Vega García, Héctor Argüello Rodríguez
Una correcta implementación de las estrategias de bioseguridad es de vital importancia para poder mejorar las condiciones sanitarias, productivas, de bienestar y medioambientales en las granjas porcinas. Estas estrategias establecerán también las bases en las que se asentará la medicina preventiva en estas explotaciones.


store.grupoasis.com +34 910 003 892 store@grupoasis.com NOVEDAD EDITORIAL 5% DESCUENTO ENVÍO GRATIS* * Envío gratis para Península y Baleares. Bioseguridad en producción porcina
“En esta edición hemos hecho una gran apuesta por la sostenibilidad, la digitalización y el bienestar animal”
Del 28 al 31 de marzo FIGAN volverá a convertirse en el punto de encuentro más importante para el sector agropecuario en el Arco Mediterráneo. La Feria Internacional para la Producción Animal, que este año celebra su edición número 16, se ha posicionado como el mejor foro de intercambio de experiencias, información y conocimiento.
Javier
FIGAN 2023 está a punto de celebrarse. ¿Cuáles son, en su opinión, los puntos fuertes de este certamen?
A menos de un mes para la celebración, tenemos confirmada la asistencia de más de 900 marcas expositoras, que ocuparán una superficie de más de 77.000 metros cuadrados en 6 pabellones. Van a ser cuatro días repletos de actividad, para lo que estamos trabajando en un extenso programa de jornadas técnicas, que contará con más 40 actividades, así como el concurso de Novedades Técnicas y el premio excelencia FIGAN. Y todo ello, sin olvidar el pabellón 7, que alojará a más de 800 cabezas de ganado vivo de las principales razas.
En cada edición tratamos de ofrecer el margen de mejora que demanda el sector y continuamos dando respuesta sus necesidades. Nos encontramos en un sector que, entre otras variables, evoluciona hacia la ganadería de precisión y un desarrollo constante en la tecnología. Por ello, en esta edición hemos apostado fuertemente por la sostenibilidad y la digitalización, así como por el bienestar animal.
FIGAN 2023 será un certamen en el que el visitante podrá encontrar, no solo productos y servicios, sino también jornadas, novedades técnicas, asambleas, reuniones sectoriales y profesionales. En definitiva, FIGAN concentrará al sector como foro de intercambio de experiencias, información y conocimiento.
En este sentido, ¿qué novedades nos vamos a encontrar este año?
Como comentaba anteriormente, FIGAN ha hecho una apuesta firme por la digitalización y la sostenibilidad. En este sentido, en esta edición no habrá invitaciones en papel para visitar FIGAN, sino que todos los profesionales deberán registrarse online. Además, FIGAN contará con los Digital Info Points de Mixie, en los que los visitantes tendrán a su disposición y a través de la app de FIGAN la posibilidad de obtener información de los stands (catálogos, fichas técnicas, fotos, videos, etc.), sin necesidad de cargar con documentación durante su visita. Hemos trabajado para facilitar la visita de los profesionales y la interacción con los expositores.
Por otro lado, cabe destacar que nuestros expositores, hacen una apuesta fuerte por la ganadería de precisión. Hemos visto un salto cualitativo y cuantitativo en desarrollos en sensórica, control y medición para el bienestar animal, la sostenibilidad medioambiental, así como una mejora en equipamiento y desarrollos para la mejora de procesos. Como novedad en el sector expositivo, el visitante profesional podrá ver, junto con los sectores ya presentes en ediciones anteriores, un aumento de la oferta expositiva en el sector de la integración y en el de las energías renovables, además de animales vivos, equipamiento e instalaciones, genética, alimentación, sanidad, organizaciones e instituciones, etc.
 Camo
Jefe del Área Agroalimentaria de Feria de Zaragoza y Director de la Feria Internacional para la Producción Animal, FIGAN
Camo
Jefe del Área Agroalimentaria de Feria de Zaragoza y Director de la Feria Internacional para la Producción Animal, FIGAN
ENTREVISTA 38 ■ SUIS Nº 195 Marzo 2023
La digitalización y la visibilización del papel de la mujer en la ganadería son algunos de los objetivos que se ha propuesto ¿De qué manera se están implementando?
FIGAN es sinónimo de innovación, así que la digitalización ha sido una de nuestras grandes apuestas para esta edición. Digitalización que en esta edición va unida a una mejora en sostenibilidad como ya hemos indicado.

Hemos incorporado nuevas herramientas para expositores y visitantes que mejoran el acceso a toda la información referente al certamen, sin duda un elemento que mejora enormemente el modelo de negocio del salón. Para ello, contamos con una app que muestra toda la información útil: planos de los pabellones, listado de expositores, ubicaciones, servicios, horarios, etc., todo para que la visita a FIGAN sea más útil y productiva. Además, dentro de esta app contamos con un elemento diferenciador: los Digital Info Points. Se trata de una herramienta para optimizar la visita a Feria de Zaragoza, ya que permitirá recibir información en tiempo real, preparar agendas de contactos, y recibir información de presentaciones y jornadas técnicas, entre otras utilidades destacadas. En cuanto al papel de la mujer en la ganadería, una importante novedad de esta edición es el reconocimiento que el certamen muestra hacia las profesionales del sector; se trata de poner en valor el papel
Pabellones 4-5
■ Equipamiento e instalaciones vacuno, ovino y caprino
■ Ordeño e industria láctea
■ Equipos para fábricas de pienso
■ Maquinaria
■ Transporte de animales
■ Agroenergía y gestión ambiental

■ Instituciones y organizaciones agrarias
de la mujer en el medio rural. Podrán verlo en la cantidad de jornadas que serán abanderadas e impartidas por mujeres, en el marco de las jornadas técnicas que estamos programando. Por medio de esta acción, queremos poner de manifiesto la importancia de las mujeres en el sector pecuario, su capacidad de gestión y de emprendimiento. Ellas cada vez tienen más protagonismo en este sector y deben ser ejemplo de gestión de talento para generaciones futuras.
Y, en concreto, para el sector porcino, en su opinión ¿qué va a ser lo más destacable? El sector porcino español es una referencia en todo el mundo. No hay más que ver las cifras de exportación que se generan desde nuestro país. Tenemos grandes profesionales al frente de este sector, tanto en las explotaciones ganaderas como en la línea final en sacrificio.
En FIGAN podremos encontrar los principales fabricantes de todos los sectores orientados al sector porcino, ofreciendo un punto de encuentro entre empresas y los profesionales, buscando soluciones a los importantes retos que se enfrenta el sector, y poniendo en valor las buenas prácticas de gestión, a nivel social, económico y medioambiental. El visitante profesional podrá encontrar numerosas novedades en gestión de purines, granjas inteligentes, sensórica, nuevos sistemas de medición, etc.
Pabellón 6
■ Acuicultura
■ Alimentación
■ Sanidad
■ Genética
■ Mataderos y salas de despiece
■ Publicaciones y prensa técnica
Pabellón 7
■ Animales vivos
■ Asociaciones
■ Servicios
Pabellón 8
■ Equipamiento e instalaciones avícolas, porcino y cunícola
■ Gestión medioambiental
■ Informática aplicada
Stand 4

ENTREVISTA
Calle F-G, Nº 19-22
SUIS Nº 195 Marzo 2023 ■ 39
Vacunación frente a ileítis en cerdas de reposición: una propuesta de valor
En el contexto actual, con altos costes de producción y márgenes muy ajustados, el control de las patologías digestivas es fundamental para la rentabilidad de las granjas de cerdos. Las recomendaciones en el uso muy ajustado de tratamientos antimicrobianos, en consonancia con la estrategia global de una sola salud, hacen que los programas vacunales sean una herramienta clave en el control de enfermedades.
El sector porcino español lleva años inmerso en un proceso continuo de mejora, que le ha convertido en una referencia a nivel mundial. Avanza y mejora día a día en diferentes aspectos: bienestar animal, nutrición, bioseguridad, sanidad, reproducción y, muy importante, en genética. Todo ello hace posible obtener mejores resultados en las granjas, siendo más eficientes. Pero, para que los animales puedan alcanzar su máximo potencial productivo, la sanidad es fundamental. La prevención de enfermedades basada en la bioseguridad y los programas vacunales, sobre todo si pensamos en las cerdas de reposición, que son el futuro y el motor de las granjas, es uno de los pilares para seguir mejorando como sector.

LA CERDA DE REPOSICIÓN
Debemos considerar a las cerdas de reposición como una inversión, no solo económica, sino de
tiempo y atención. Estas nacen con un potencial genético que las hará ser más productivas que las cerdas a la que van a sustituir, y nos interesa que alcancen una longevidad adecuada, lo que contribuirá a conseguir el equilibrio censal, la estabilidad sanitaria y la rentabilidad de nuestras granjas. Para que esto se cumpla debemos planificar y realizar con ellas un manejo diferenciado desde su nacimiento, no solo a partir de su introducción en el grupo de cerdas de producción. Es importante seguir las directrices que marcan las empresas de genética, trabajando coordinadamente, ya que son ellas las que mejor conocen a sus animales y cómo obtener de ellas el máximo rendimiento.
LA ILEÍTIS PORCINA
La ileítis, causada por Lawsonia intracellularis (L.i), es una enfermedad con una gran repercusión
Alfredo Romero, Jesús Bollo, Paula Herrero, Marta Jiménez, Rut Menjón y Marcial Marcos.
MSD Animal Health
SECCIÓN MSD ANIMAL HEALTH 40 ■ SUIS Nº 195 Marzo 2023
Figura 1. Lote de cerdas de reposición.
en la producción porcina, al ser responsable no solo de pérdidas directas por muertes de animales, sino indirectas al afectar a la transformación del pienso en carne.
En un estudio llevado a cabo en España en 2020, se obtuvieron resultados de laboratorio procedentes de 31 granjas/casos clínicos de campo que reportaron problemas entéricos de cerdos en crecimiento no vacunados frente a L.i. Como resultado, un 27,9 % de los PCR individuales y un 32,4 % de los pools dieron resultado positivo, mostrando de nuevo la buena correlación entre ambos tipos de agrupamiento de las muestras. Por otro lado, el 100 % de las granjas fueron positivas a ELISA en la fase de engorde, con un 70 % de prevalencia máxima individual en los cerdos de mayor edad. Bajo las condiciones de este estudio, podemos destacar la alta presencia de esta bacteria en las granjas españolas.Se puede considerar que la ileítis tiene tres formas de presentación:
■ Forma aguda. Afecta esencialmente a animales a partir de cuatro meses de edad y produce una grave diarrea hemorrágica con heces sanguinolentas de aspecto alquitranado. Este proceso puede llegar a provocar una mortalidad cercana al 50 % si no se lleva a cabo un tratamiento antimicrobiano adecuado. Esta es la forma de presentación más habitual en las cerdas de reposición.
■ Forma crónica. Aparece en animales en crecimiento, a partir de las seis semanas de vida y hasta su envío a los centros de procesado. Es mucho más común. Los cerdos afectados presentan diarrea con distintos niveles de consistencia (desde heces líquidas a “blandeos”) y coloración. Fundamentalmente esto trae aparejado un descenso en la ganancia media diaria y, en consecuencia, la aparición de una elevada desigualdad dentro del lote. En este caso, la mortalidad se puede ver un poco aumentada, pero sin graves consecuencias.
■ Forma subclínica. Se caracteriza por su casi nula mortalidad y aparición de heces pastosas en algunos animales del lote de forma esporádica, que provoca una pérdida de crecimiento de los animales, junto con un empeoramiento de los índices zootécnicos. La desigualdad también aparece en este caso, pero es menos evidente. Por consiguiente, la identificación de esta forma subclínica es complicada.

Según algunos estudios, la dinámica de infección de Lawsonia intracellularis cambia en cada lote, tanto en relación con el inicio de infección como con su posterior evolución. Para no subestimar las posibles consecuencias de una infección por L.i. será necesario recolectar muestras de heces o sangre a diferentes edades, para intentar hacer coincidir el momento del muestreo con el pico de infección, e incluir varios lotes para representar las fluctuaciones de la dinámica de infección.
LA VACUNACIÓN DE LAS CERDAS DE REPOSICIÓN FRENTE A LA ILEÍTIS
La vacunación es una de las estrategias de control sanitario más extendida en todo el mundo, tanto en salud humana como animal. En la clínica porcina, la vacunación ha sido (y es) clave para prevenir, controlar, e incluso erradicar algunas patologías, tanto bacterianas como víricas, que afectan a cerdas y lechones. Las cerdas de reposición son un punto clave en la estabilidad sanitaria y la bioseguridad de la granja, ya que su estatus sanitario/inmunitario no siempre coincide con el de la granja de destino. Por ello, hemos de ser muy meticulosos con la introducción de este grupo de animales en la granja, realizando primero un aislamiento y cuarentena, periodo que aprovecharemos para identificar de manera precoz los primeros síntomas de enfermedad, y hacer controles serológicos y otras técnicas de diagnóstico para conocer su estatus sanitario. El siguiente paso es la adaptación a la granja de destino, momento en el que implementaremos el programa vacunal preventivo diseñado según la situación concreta. Las cerdas de reposición se vacunarán en sus etapas iniciales como cualquier otro lechón, pero antes de introducirlas en los lotes de producción deben prepararse para estar protegidas frente a los desafíos a los que se enfrentarán posteriormente.
El mercado demanda estrategias vacunales que permitan reducir el manejo sin perder eficacia. Desde el punto de vista de la bioseguridad interna, para evitar la transmisión de enfermedades dentro de la granja, un punto importante es reducir el número de aplicaciones con aguja que hacemos a los animales, para lo cual es bueno utilizar vacunas multivalentes, vacunas combinables y/o de uso simultáneo, o el sistema IDAL® de vacunación intradérmica sin aguja, que, además de tener una ele-
SECCIÓN MSD ANIMAL HEALTH SUIS Nº 195 Marzo 2023 ■ 41
Figura 2. Vacunación intradérmica sin aguja con el sistema IDAL®
vada eficacia, mejora el bienestar de los animales, reduce la transmisión iatrogénica de enfermedades y mejora la seguridad alimentaria, al reducir el riesgo de aparición de agujas en las canales. En esta línea, MSD Animal Health ha obtenido recientemente el registro para uso simultáneo de cuatro vacunas: Porcilis® PCV ID, Porcilis® Lawsonia ID, Porcilis® M Hyo ID y Porcilis® PRRS ID, que permite inmunizar frente a cuatro de los principales patógenos que afectan al ganado porcino en un solo manejo de los animales. No todos los programas de control de una enfermedad han de ser iguales. En el caso de la ileítis, sus distintas formas de presentación según el tipo de animales a los que afecta (cerdas gestantes, cerditas de reposición, animales en crecimiento de distintas edades) precisan tener también diversos patrones de control.
¿CUÁNDO VACUNAR FRENTE A ILEÍTIS UNA CERDA DE REPOSICIÓN?
Debemos tener en cuenta cuatro puntos para determinar el momento y la pauta óptima de vacunación:
■ Cuándo necesitamos que estén los animales protegidos antes de enfrentarse al desafío de la infección.
■ Desde qué momento se puede poner la vacuna.
■ Cuánto tarda en generarse la inmunidad tras la administración de la vacuna.
■ Cuánto dura la inmunidad desde la aplicación. En el caso de Porcilis® Lawsonia y Porcilis® Lawsonia ID, ambas son vacunas que se pueden administrar desde las 3 semanas de edad, con un periodo de 4 semanas para la instauración de la inmunidad y durando esta inmunidad 21 semanas desde la aplicación.
Con estas premisas podemos considerar:
■ Vacunar lechonas a partir de las 3 semanas de edad, para que estén protegidas durante su fase de crecimiento. Si estos animales se van a mover a granja de producción pasadas 21 semanas desde su vacunación, sería conveniente poner una dosis de recuerdo antes del traslado, para que cuando lleguen a la granja de destino estén bien protegidas. Debido al alto valor genético de estos anima-
les, recomendamos esta pauta de vacunación de dos dosis antes de entrar en la fase reproductiva.
■ Cuando no hay problemas en la fase de crecimiento, vacunar a las cerditas mínimo 4 semanas antes de su envío a la granja de destino, para que lleguen protegidas y evitar la presentación clínica de la enfermedad.
Consideramos que, cuando sean necesarios, estos programas deben estar consensuados entre los responsables sanitarios de las granjas de origen y recepción de las cerdas de reposición, y recogidos en las pautas marcadas por las empresas de genética, para así favorecer que las cerdas alcancen todo su potencial genético.
CONCLUSIONES
Queremos finalizar destacando una serie de aspectos que consideramos importantes y que hemos de tener muy en cuenta:
■ Hoy más que nunca el control de las patologías digestivas, con un uso reducido de antibióticos, es clave para la rentabilidad y el futuro de las granjas de cerdos.
■ La prevención de enfermedades, basada en la bioseguridad y los programas vacunales, es fundamental, sobre todo si pensamos en las cerdas de reposición.
■ La ileítis porcina es muy prevalente y genera graves pérdidas económicas, al ser responsable no solo de pérdidas directas por muertes de animales, sino indirectas al afectar a la transformación de pienso en carne.
■ Para prevenir estos efectos negativos es conveniente incluir la vacunación frente a ileítis en los programas habituales de las granjas de producción, sobre todo en los de adaptación de cerdas de reposición, ya que ellas pueden sufrirla de forma aguda y desestabilizar el equilibrio sanitario de las granjas donde llegan.
■ Porcilis® Lawsonia o Porcilis® Lawsonia ID se pueden utilizar de forma aislada para inmunizar solo frente a ileítis, o mezclada y de forma simultánea para proteger hasta frente a 4 antígenos en un solo manejo de los animales.
BIBLIOGRAFÍA
Ficha técnica Porcilis Lawsonia. https://cimavet.aemps.es/cimavet/pdfs/es/ft/3814+ESP/FT_3814+ESP.pdf
Ficha técnica Porcilis Lawsonia ID. https://cimavet.aemps.es/cimavet/pdfs/es/ft/3961+ESP/FT_3961+ESP.pdf
Romero A. et al La cerda de reposición: una inversión rentable. SUIS 182, noviembre 2021.
Marcos M. et al. Diferentes estrategias y sus resultados para el control de Lawsonia intracellularis. SUIS 191, octubre 2022.
Jiménez M. et al. Eficacia y facilidad de manejo: la clave del éxito de las vacunas combinadas en porcino. SUIS 193, diciembre 2022.
Estabilidad sanitaria: pieza clave para la mejora de la eficiencia en granja. https://porcinews.com/monograficos/seccion-ileítis-porcina/
Estabilidad sanitaria para mejorar el coste de producción. https://porcinews.com/estabilidad-sanitaria-para-mejorar-el-coste-de-producción/ Diseases of Swine, Eleventh Edition. Jeffrey J. Zimmerman et al. 2019.
SECCIÓN MSD ANIMAL HEALTH 42 ■ SUIS Nº 195 Marzo 2023

Vacunación de cerdas frente a PCV-2: ¿podemos reducir la transmisión vertical?
Es innegable que la vacunación frente a la Circovirosis Porcina supuso un gran hito en la prevención de enfermedades infecciosas porcinas. La evidente mejoría de la sintomatología clínica de desmedro, la reducción de la mortalidad y la mejora de los parámetros productivos motivaron que la práctica totalidad de los lechones fueran vacunados sistemáticamente.
En España, se estima que, actualmente, la vacunación se aplica casi al 100 % de los lechones y, aunque se está observando un incremento considerable, lo cierto es que la vacunación de las reproductoras está en cifras muy inferiores a las de su descendencia. La vacunación generalizada de los lechones, junto a los beneficios mencionados anteriormente, ha contribuido a una reducción de la excreción del virus y, por tanto, de la circulación vírica en la población porcina dejando por el camino algunas subpoblaciones inmunológicas. Es lo que se conoce como el cambio epidemiológico de PCV-2.

Ante esta situación, se dibujan nuevos escenarios donde el PCV-2 vuelve a tener cierto protagonismo generando poblaciones de cerdas reproductoras
inestables al virus. De este modo, no es infrecuente en la actualidad encontrar estas subpoblaciones inmunológicas en algunas granjas de madres. Esto provoca un incremento de la infección intrauterina, con las consecuencias que conlleva tanto para la madre a nivel reproductivo, como para sus lechones, ya que se incrementa la prevalencia de la infección a edades más tempranas.
En los últimos años, la infección intrauterina y el impacto de la vacunación de las madres sobre dicha transmisión fetal han sido investigados en suero de lechones recién nacidos1,2 y en cordones umbilicales de lechones neonatos3,4
Con el propósito de actualizar estos hallazgos, a continuación, se expone un estudio que fue presentado en la Leman Conference de 2022 celebrada en Saint Paul (Minnesota). Se trata de una investigación que describe, por un lado, la utilidad del monitoreo de este patógeno mediante qPCR realizado sobre muestras de lenguas de lechones nacidos muertos para detectar la inestabilidad a PCV-2 de los colectivos de reproductoras. Y, por otro, muestra el impacto positivo que tiene la vacunación en sábana de las
SECCIÓN BOEHRINGER INGELHEIM
adriaticfoto/shutterstock.com 44 ■ SUIS Nº 195 Marzo 2023
cerdas con Ingelvac CircoFLEX® sobre esta transmisión intrauterina medida con este tipo de muestras. Todo ello en una población de reproductoras donde el genotipo de virus que infectaba a los animales fue secuenciado y correspondía con PCV-2d.
En este punto es importante recordar que dicho genotipo es el que actualmente está circulando con predominancia en la población porcina, sin consecuencias en términos de eficacia de las vacunas basadas en PCV-2a, como es el caso de Ingelvac CircoFLEX®.
INTRODUCCIÓN
La infección por circovirus porcino 2 (PCV-2) en las cerdas puede tener un impacto negativo en el rendimiento de las reproductoras y también puede suponer la transmisión vertical transplacentaria del virus. La vacunación de las cerdas contra el PCV-2 ha demostrado ser eficaz para reducir la transmisión vertical, como se comprobó en sangre de lechones recién nacidos3 o incluso en el suero de cordones umbilicales placentarios3,5.
La toma de muestras de la lengua de animales muertos se ha descrito como una forma adecuada de detectar la circulación del virus del PRRS en el rebaño de cerdas, así como la transmisión vertical de las madres virémicas a sus crías6. El objetivo de esta investigación fue evaluar el impacto de la vacunación frente a PCV-2 de las cerdas sobre la evolución de la detección de PCV-2 en muestras de lenguas, tanto cualitativa como cuantitativamente.

MATERIALES Y MÉTODOS
La investigación se llevó a cabo en una granja comercial de 3.000 cerdas. Se tomaron muestras de lenguas de todos los mortinatos en cada lote semanal de partos, antes de la vacunación de las cerdas (n = 15 semanas) y después de la vacunación (n = 15 semanas) con 1 ml de Ingelvac CircoFLEX® por vía intramuscular. Las muestras fueron tomadas por personal de la granja que cortaba la punta de la lengua (2 cm) cada día de parto (figura 1), se agrupaban en una bolsa de plástico de 100 muestras y se almacenaban a -20 °C hasta su recepción en el laboratorio de diagnóstico. Los muestreos se realizaron entre la semana 47 del año 2020 y la semana 30 del 2021. En las semanas 10 y 14 de 2021 se vacunó en sábana a las cerdas.
Tras la descongelación y la extracción del ADN, se evaluó la carga viral del PCV-2 mediante una
qPCR (TaqVet Porcine CircoVirus 2 (RT-PCR)) y los resultados se expresaron como el log10 de las copias de material genético. La secuenciación del ORF2 del PCV-2 se realizó con fines de genotipado.
La comparación tanto del porcentaje de muestras positivas como de la carga viral de dichas muestras positivas en cada periodo se realizó con una prueba X2 (con cálculo del odds ratio) y una prueba de mediana de Mood, respectivamente, y se consideró estadísticamente significativa una
para cada periodo.
= 0,003 para las diferencias entre antes y después de la vacunación de las cerdas (Odds ratio = 0,09).
SECCIÓN BOEHRINGER INGELHEIM
R. Alvarez1 y Dr. S. Figueras2
1Agroturia SA (España) 2Boehringer Ingelheim Animal Health (España)
Reducción de la detección de PCV-2d en muestras de lengua de lechones mortinatos tras la inmunización de las madres con una vacuna frente basada en PCV-2a
Figura 1. Muestras de lengua.
Positivo Negativo Total Antes 11a 4a 15 (74 %) (26 %) Después 3b 12b 15 (20 %) (80 %) a,b p
Tabla. Lenguas positivas y negativas a PCV-2d en la PCR
SUIS Nº 195 Marzo 2023 ■ 45
Figura 2. Gráfica de valores individuales de la carga de PCV-2d (log10) en la qPCR antes y después de la vacunación (p = 0,003).
p < 0,05. Para el análisis estadístico se utilizó el software Minitab v20.

RESULTADOS
No se observaron reacciones adversas (fiebre o abortos) en las cerdas tras la vacunación y la revacunación en sábana con Ingelvac CircoFLEX®. En esta población se detectó que el genotipo circulante era el PCV-2d. En general, el porcentaje de muestras qPCR positivas se redujo significativamente tras la vacunación (tabla). Además, en la qPCR se observó una reducción significativa de la carga de PCV-2d tras la vacunación de las cerdas (figura 2).
CONCLUSIONES
En esta granja de cerdas, la vacunación y revacunación de todo el colectivo con Ingelvac CircoFLEX® resultó en una reducción de la detección de
Después
muestras positivas a PCV-2d en las semanas siguientes a la intervención. La reducción en la frecuencia de muestras positivas y en la carga viral de PCV-2d en las muestras semanales sugeriría una reducción en la transmisión vertical como consecuencia de la vacunación de las cerdas. El novedoso y cómodo muestreo de las lenguas de lechones mortinatos podría proporcionar una manera fácil de monitorizar la estabilidad del PCV-2 en los hatos reproductores, como ya se realiza para el virus PRRS6.
REFERENCIAS
1. Viñeta J., 2015 ESPHM Proc. P161
2. Navas, J. et al. IPVS 2016. VO-PT2-254.
3. Figueras, S. et al. IPVS 2018. Proc. I-189 p 552.
4. Pleguezuelos, P et al. Porcine health management 7 (2021): 1-12.
5. López, S. et al. ESPHM 2017 Oral presentation.
6. Baliellas, J. et al. (2021) Veterinary Sciences 8 (11):259.
6 5 4 3 2 1 0 PCV-2d qPCR log 10 Antes
46 ■ SUIS Nº 195 Marzo 2023 SECCIÓN BOEHRINGER INGELHEIM
Ficha técnica Ingelvac CircoFLEX®

1Servicio técnico Uvesa; 2Servicio técnico
Animal Adaptación de “Exploratory field study on the effects of sow vaccination against PRRSv using combined protocols on piglet viraemia at weaning”. Proceedings of 13th European Symposium of Porcine Health and Management, 11-13 May 2022, Budapest.

Efecto sobre la viremia en lechones al destete con el empleo en reproductoras de vacuna atenuada e inactivada frente a PRRS
Uno de los principales agentes patógenos que puede afectar al ganado porcino es el virus del Síndrome Reproductor y Respiratorio Porcino (PRRSV). Desde su detección a principios de los 90 en España, continúa siendo una de las enfermedades que ocasiona más pérdidas económicas en el sector porcino. Esas pérdidas económicas son variables dependiendo de la gravedad de la clínica reproductiva y/o respiratoria observada en cada caso, y según la cepa de PRRSV que esté implicada en el mismo. Un estudio realizado por Nathues y cols. (2017) cuantificó que el coste de la enfermedad puede oscilar entre 100 y 650 € por cerda y año, según el escenario clínico observado. En la misma línea, un estudio publicado recientemente, realizado en Alemania, simuló el coste del PRRSV en las granjas incluidas en el estudio en una media de 255 €/cerda-año (Renken et al., 2021).
Las estrategias o programas de control frente a PRRS se basan en bioseguridad, vigilancia epidemiológica mediante la monitorización de granjas y cepas presentes, y en la implementación de programas de vacunación. En los últimos años, dentro de estos programas de control del PRRS, se han utilizado protocolos de vacunación de las cerdas reproductoras que combinan vacunas atenuadas con inactivadas (Nilubol, 2007; Dekens, 2013; Díaz et al., 2013; Deefort, 2014; Knockaert, 2015; Willems, 2015; Boivent, 2016; Spaans, 2016).
Estos protocolos están basados en la Tecnología
Dual de Refuerzo Inmunitario (TDRI, en inglés
DTPB-Dual Technology Prime Booster), que pueden suponer una alternativa eficaz para estabilizar la situación sanitaria frente al PRRS en las granjas tras un brote.
MATERIAL Y MÉTODO
En este sentido, se realizó un estudio cuyo objetivo fue evaluar el efecto de la vacunación de las reproductoras frente a PRRSV utilizando protocolos combinados de vacunas atenuadas e inactivadas
sobre la viremia de los lechones al destete. Este estudio se realizó en una granja convencional (fase 1 y 2) de 2.800 cerdas reproductoras que estaba sufriendo un brote de PRRS. Inicialmente, las reproductoras fueron vacunadas en sábana utilizando una vacuna viva atenuada dos veces, con un intervalo de 4 semanas, siguiendo el protocolo habitual de la granja tras un brote de PRRS. Cuatro semanas después, se realizó una sábana con una
SECCIÓN CEVA
C. Agüero1, Susana Mesonero-Escuredo2, D. Espigares2 y L. Garza2
Ceva Salud
48 ■ SUIS Nº 195 Marzo 2023
Ggamies/shutterstock.com
vacuna inactivada (Progressis®, Ceva) y tras esto, se implementó la vacunación de las reproductoras con la misma vacuna inactivada en ciclo, 4 semanas antes del parto.
Para monitorizar la situación sanitaria de la granja frente a PRRSV, se tomaron muestras de sangre de 30 lechones por lote al destete cada 6 semanas. Este muestreo se inició tras la administración de la vacunación en sábana de las reproductoras con Progressis®. Además, se tomaron muestras semanalmente de lenguas de nacidos muertos y bajas

en lactación de cerdas multíparas y nulíparas para aumentar el tamaño muestral. Las muestras de sangre se procesaron en pools de 5 muestras y el pool de lenguas recogido semanalmente de forma individual. Ambas se testaron mediante RT-PCR (LSI VetMax PRRSV EU/NA, Thermo Fisher Scientific) para la detección del virus. Además, con el objetivo de monitorizar la transferencia de inmunidad maternal frente a PRRS, las muestras de sangre se testaron para serología con el kit PRRS IDEXX ELISA (IDEXX, Westbrook,
Tabla. Resultados de la detección del virus PRRS por RT-PCR en las muestras tomadas de los distintos lotes de lechones muestreados al destete.
Muestras de lechones al destete (n = 30)
Pool 1 Pool 2 Pool 3
Pool 4
Pool 5 Pool 6
Muestreo 1 (Ct) Positivo (32) Positivo (27) Positivo (31) Positivo (24) Positivo (29) Positivo (28)
Muestreo 2 (Ct) Negativo - Negativo - Negativo - Negativo - Positivo (25) Positivo (20)
Muestreo 3 (Ct) Negativo - Negativo - Negativo - Negativo - Negativo - Negativo -
Muestreo 4 (Ct) Negativo - Negativo - Negativo - Negativo - Negativo - Negativo -
Muestras de lengua de NM y bajas en lactación
Muestreo 5 (Ct) Negativo - Negativo - Negativo - Negativo - Negativo - Negativo - 1/6 Multíparas
Muestreo 6 (Ct) Negativo - Negativo - Negativo - Negativo - Negativo - Negativo - Negativo -
Muestreo 7 (Ct) Negativo - Negativo - Negativo - Negativo - Negativo - Negativo - Negativo -
Muestreo 8 (Ct) Negativo - Negativo - Negativo - Negativo - Negativo - Negativo - Negativo -
Muestreo 9 (Ct) Negativo - Negativo - Negativo - Negativo - Negativo - Negativo - NegativoNM: nacidos muertos.
SECCIÓN CEVA
SUIS Nº 195 Marzo 2023 ■ 49
Daisy Daisy/shutterstock.com
USA) de forma individual. En total, se muestrearon 9 lotes de lechones, lo que supuso un total de 270 lechones, y 5 lotes semanales mediante la recogida de lenguas de nacidos muertos y bajas. Los resultados de la evolución de la viremia detectada en los distintos lotes de lechones se muestran en la tabla, así como la monitorización de los lotes mediante el análisis de las lenguas de nacidos muertos y bajas en lactación.

RESULTADO
Cabe destacar que el primer lote de lechones destetados negativos (muestreo 3, tabla) coincidió con el primer lote de lechones procedente de cerdas vacunadas en ciclo. Este flujo de lechones destetados negativos se mantuvo durante los siguientes lotes, que también procedían de reproductoras vacunadas en ciclo. Estos resultados sugieren que la vacunación de las reproductoras con protocolos combinados de vacuna atenuada e inactivada en sábana, así como vacunación de las reproductoras con inactivada en ciclo, podrían ser una estrategia útil para controlar la viremia en los lechones al destete y estabilizar así la circulación del virus en la granja. Respecto a los resultados de la serología, la figura muestra los promedios de densidad óptica obtenidos en los distintos muestreos. Estos indicaron que los lechones procedentes de cerdas reproductoras vacunadas en ciclo mostraron valores que se mantenían similares durante los distintos muestreos realizados a lo largo de la monitorización del estudio, sugiriendo una mayor homogeneidad en la transferencia de inmunidad maternal frente al PRRSV.
CONCLUSIÓN
En resumen, los resultados de este estudio indican que los protocolos de vacunación de PRRS basados en la combinación de vacunas atenuadas e inactivadas pueden resultar una estrategia útil para la estabilización del PRRSV en las granjas afectadas, así como para aumentar y homogeneizar la inmunidad maternal de los lechones frente a este patógeno durante las primeras semanas de vida.
1,000 0,900 0,800 0,700 0,600 0,500 0,400 0,300 0,200 0,100 0 DO PRRS IDEXX Muestreos M2 M3 M4 M5 M6 M7 M8 M9 Remberto Nieves/shutterstock.com 50 ■ SUIS Nº 195 Marzo 2023 SECCIÓN CEVA
Figura. Resultados de la serología frente a PRRS en las muestras tomadas de los distintos lotes de lechones muestreados al destete.

Empresas
Boehringer Ingelheim patrocina las Jornadas de Porcino de la UAB y AVPC
La Universitat Autònoma de Barcelona acogió del 1 al 3 de febrero las Jornadas de Porcino de la UAB y AVPC, una cita clásica en el calendario que ha celebrado su 25 aniversario con un evento que ha logrado reunir a más de 200 asistentes. Boehringer Ingelheim Animal Health España acudió al evento en calidad de patrocinador, mostrando, una vez más, su compromiso con la formación y la actualización de los profesionales, que queda también patente en la nueva plataforma SoloPorcino (www.so-
Zona Porcino: una comunidad asentada que supera ya los 1.300 profesionales
Zona Porcino, la iniciativa de Zoetis España dirigida a los veterinarios de porcino principalmente, pero también a otros profesionales relacionados con el sector, con el objetivo de ofrecerles información veraz y actualizada sobre distintas áreas de la producción porcina, cerró 2022 superando sus expectativas. El proyecto, que comenzó su andadura hace algo más de tres años, ha ido creciendo y forjando toda una comunidad de expertos que hoy en día concentra a 1.330 profesionales.
loporcino.es), web informativa y formativa para los profesionales de la salud porcina. Con el formato habitual, el 25 aniversario de este congreso se articuló en tres jornadas. La primera de ellas se centró en talleres temáticos en las que abordaron cuestiones como el control de aguas, la interpretación de fórmulas de pienso, limpieza y desinfección, la resolución de hernias en porcino y manejo en bandas. La segunda y tercera jornada se centraron en mesas redondas en torno a Strep
Ceva Salud Animal participa en las XXV Jornadas Técnicas de Porcino de la UAB y AVPC

Ceva Salud Animal no faltó a su cita con las XXV Jornadas Técnicas de Porcino de la Universidad Autónoma de Barcelona (UAB) y la Asociación de Veterinarios de Porcino de Catalunya (AVPC), celebradas del 1 al 3 de febrero. Además de colaborar activamente con el encuentro, la compañía impartió un taller en el que Carlos Casanovas, del Servicio Técnico de Porcino, abordó el manejo en bandas como herramienta para lograr la estabilidad sanitaria.
suis, PPA y PRRS. Además, el programa se completó con la presentación de casos clínicos y de trabajos realizados en la UAB/CReSA.
Zoetis apoya un año
más las Jornadas de Porcino de la UAB y la AVPC
La Universidad Autónoma de Barcelona (UAB) y la Asociación de Veterinarios de Porcino de Cataluña (AVPC) celebraron sus XXV Jornadas de Porcino, patrocinadas un año más por Zoetis. En el programa de ponencias, destaca una mesa redonda celebrada el 2 de febrero en la que expertos de primera línea debatieron y cuestionaron si es posible hacer frente a Streptococcus suis sin el empleo de amoxicilina. El debate estuvo precedido por la intervención del reconocido veterinario Enric Marco.
Farm Faes va más allá de la nutrición animal con el servicio de cálculo de la huella de carbono de los piensos
En Farm Faes destacan la sostenibilidad como elemento indispensable para el sector agroalimentario, considerándola una necesidad a nivel social, económico y ambiental. Una sostenibilidad que tiene que ser compatible con la eficiencia productiva de las explotaciones ganaderas para asegurar su viabilidad y fomentar el desarrollo del ámbito rural.
Desde el Departamento de Sostenibilidad y Medioambiente de Farm Faes han trabajado en el cálculo de la huella de carbono (HC), tanto de la organización como de
los productos. Para ello, desarrollan una herramienta para cuantificar la HC de los piensos, siguiendo la metodología de la Product Enviromental Footprint (PEF).
Este nuevo servicio proporciona información a los clientes sobre la huella de carbono de los productos e incorporar datos de impacto en la formulación de Farm Faes. Además, permite analizar puntos críticos en los procesos de fabricación de piensos e implementar medidas que ayuden a la disminución de GEI.
tenibilidad sea una realidad en sus fábricas y en el sector. Ir más allá de la nutrición animal implica colaborar con sus clientes ante uno de los principales retos: la sostenibilidad ambiental de la ganadería.

En Farm Faes trabajan para que la sos52 ■ SUIS Nº 195 Marzo 2023
EMPRESAS
MSD Animal Health patrocinó las XXV Jornadas
Técnicas de Porcino de la UAB y la AVPC
Las XXV Jornadas

Técnicas de Porcino de la UAB y la AVPC se desarrollaron los pasados días 1, 2 y 3 de febrero en el Hotel Exe Campus de Bellaterra. Un año más, estas jornadas demostraron un enfoque práctico, con diferentes talleres que se realizaron el día 1, los cuales suponen una gran oportunidad de formación para los profesionales del sector. Durante los días 2 y 3 de febrero tuvieron lugar interesantes mesas redondas, como la de Strep suis: ¿Podemos trabajar sin amoxicilina?, la de PPA: ¿Y si aparece qué? y la de PRRS: ¿Cuánto invertir para controlarlo?, moderadas por Cesc Illas, Emili Revilla y Enric Mateu respectivamente. Además, la jornada contó con actividades adicionales como la presentación de casos clínicos de porcino y la divulgación de trabajos realizados en la UAB/CReSA. Con esta colaboración, MSD Animal Health ratifica su compromiso con la formación de los profesionales del sector porcino.
ya! Juan Carlos Domínguez
NOVEDADES
Ingelvac Ery, una nueva solución frente al Mal Rojo

Más información: www.boehringer-ingelheim.es






y José Ignacio Belanche

y Eva


Bioseguridad
Accede al listado completo de cursos




http://formacion.grupoasis.com INSPECCIÓN VETERINARIA EN MATADEROS DISPONIBLE 12h 69 DISPONIBLE

Agenda de cursos
¡Matricúlate
Vellarino
Para más información contacta con formacion@grupoasis.com o llámanos al 910 003 892 35h 299
Control y prevención de zoonosis
alimentaria Carme Chacón
Tolosa Curso autoaprendizaje 12h 69 DISPONIBLE
■
de transmisión
Carlos Piñeiro y
Morales Curso autoaprendizaje Curso autoaprendizaje 6h 39 DISPONIBLE
■ Mejorando la producción y la sanidad porcina a través de los datos
Joaquín
Curso autoaprendizaje
■
en granjas de ganado porcino Rafael J. Astorga
Boehringer Ingelheim lanza Ingelvac Ery, una vacuna monovalente inyectable que ofrece una respuesta inmunitaria sólida y duradera frente al Mal Rojo. Está diseñada para reducir los signos clínicos de erisipela porcina y puede administrarse durante la gestación y la lactancia. La pauta de vacunación recomendada incluye una primovacunación y una segunda dosis aplicada 4 semanas después, seguida de revacunaciones cada 5 meses. Ingelvac Ery se presenta en una caja de 50 dosis (100 ml).
Vacunación de lechones
frente a PRRS:
¿por qué?, ¿cuándo?, ¿cómo?
El control de la enfermedad del virus del PRRS sigue siendo fuente de frustración para todos los productores y veterinarios. Y, ¡no es de extrañar! Entre las razones por las que su control es tan complejo se encuentran la necesidad de un enfoque multifactorial y el hecho de que ninguna solución es única y efectiva por sí sola.
ción con otros patógenos secundarios, ya sean víricos (Gripe, PCV2.) o bacterianos (Mhyo, App, Glässer, etc.) y el gasto en antibióticos para controlar estas enfermedades.

Ante las dificultades que plantea el virus del PRRS, un correcto manejo de los animales, la inmunización adaptada en todas las edades, así como un plan de bioseguridad que reduzca el riesgo de sufrir infecciones externas y recirculaciones internas, son medidas que deben estar presentes en un plan de control de la enfermedad. En lo que respecta a la inmunización de la reposición y de las cerdas adultas con vacunas vivas modificadas, no hay mucha duda al afirmar que tiene un papel fundamental dentro de la estrategia conjunta para el control del virus. En Europa, en la actualidad, el 90 % de las reproductoras son vacunadas y sus beneficios son claros debido al impacto de la enfermedad en las granjas positivas (100-200 € por cerda/brote)1. Sin embargo, las nuevas dinámicas de la enfermedad, la presencia cada vez de más granjas positivas inestables y la recirculación periódica de cepas altamente patógenas, obliga a considerar en muchos casos no solo la vacunación de cerdas, sino también la de lechones. Y, aunque en la última década la vacunación de lechones casi se ha triplicado en España, actualmente solo un 20 % de los lechones se vacunan frente a PRRS, siendo sus beneficios y rentabilidad un foco constante de discusión.
El impacto del PRRS durante la fase de crecimiento se ha estimado en 3,5 € por un animal de 30 kg2, pero este puede ser mucho mayor si a las pérdidas directas por mortalidad y clínica asociada, sumamos las pérdidas de la posible asocia-
Y, por si todo esto fuera poco, este impacto se ha visto fuertemente incrementado en España por la cepa denominada popularmente como “Rosalía” que ha registrado altas mortalidades en transición pudiendo alcanzar en ciertas ocasiones valores de entre el 40 %3 e incluso, en casos excepcionales de hasta el 60 %.
¿QUÉ BENEFICIOS ESPERAMOS DE LA VACUNACIÓN DE LECHONES DE PRRS?
La vacunación de lechones tiene sentido cuando, alcanzando una estabilidad en la F1, existe una alta presión de infección en las transiciones, con recirculaciones víricas que impactan en el rendimiento y supervivencia de los animales en su fase de crecimiento. Si hablamos de los objetivos de la vacunación de lechones frente a PRRS, debemos destacar dos principalmente:
■ Por un lado, el control clínico de la enfermedad, reduciendo a nivel individual la sintomatología clínica y mejorando los parámetros productivos gracias a la protección de los animales frente a la infección.
■ Por otro lado, un control epidemiológico, donde buscamos conseguir una disminución de la viremia y de la excreción para reducir la presión de infección presente en la transición. A mayores, se ha demostrado que el control de la circulación de cepas de PRRS en transiciones reduce la susceptibilidad de los animales a sufrir infecciones por patógenos secundarios por lo que un tercer
objetivo sería la disminución del uso de antibióticos para el control de estas patologías.
¿QUÉ DEBEMOS TENER EN CUENTA AL VACUNAR LECHONES DE PRRS?
La vacunación de lechones frente a PRRS es cada vez una práctica más frecuente debido a que con los años hemos ido acumulando conocimiento y experiencias que han demostrado que, aplicando correctamente los protocolos vacunales, estos demuestran ser exitosos. Para asegurar la máxima eficacia de la vacunación en lechones hay que tener en cuenta que:
■ Deben vacunarse preferiblemente de 3 a 4 semanas antes de la infección.
■ Deben ser animales sanos, es decir, no virémicos.
■ Es necesario que la vacunación de lechones se realice durante un periodo mínimo de tiempo para maximizar sus
Daniel Torrents1 y Lidia de Lucas2
1Manager Servicios Técnicos Porcino, HIPRA España
54 ■ SUIS Nº 195 Marzo 2023 I+D EMPRESAS I HIPRA
2Global Product Manager, HIPRA

Figura. Reducción de la mortalidad en transición tras empezar con la vacunación con Unistrain® PRRS.
***Diferencias significativas (Test de Wilcoxon, p-valor < 0,001).
beneficios. Hablamos mínimo de 16 semanas, con diferencias entre sistemas productivos.
Por tanto, un punto clave será establecer el momento óptimo de vacunación para cada granja en función del momento de infección. Con este fin, HIPRA ha desarrollado el programa Together, que tiene como objetivo hacer un seguimiento epidemiológico y productivo de la vacunación en lechones y a su vez poder cuantificar su retorno económico.
A modo de ejemplo, presentamos los resultados de un programa realizado en una granja en España de 1.600 cerdas F1+F2 donde monitorizamos la vacunación de lechones a dos semanas de vida. Tras la confirmación diagnóstica a través de PCR y secuenciación de circulación de cepa campo, con una mortalidad media del 16 % en transición, se decidió comenzar la vacunación intradérmica con Unistrain® PRRS a dos semanas de vida.
BIBLIOGRAFÍA
Tras 3 meses de vacunación, la mortalidad se redujo en un 75 % (figura). Además, a las 8 semanas de empezar la vacunación, los lechones ya eran PCR negativos al destete y aunque seguían siendo positivos a final de transición, la secuenciación identificó en todos los casos, cepa vacunal4. Además, valorando el consumo de antibióticos y antiinflamatorios, este se redujo drásticamente tras comenzar con la vacunación de lechones. Por otro lado, la administración intradérmica con Unistrain® PRRS aporta otras ventajas añadidas tales como la reducción del riesgo de transmisión iatrogénica5 y la mejora del bienestar de los animales vacunados6
¿ES LA VACUNACIÓN DE LECHONES DE PRRS UNA HERRAMIENTA RENTABLE?
La respuesta a esta pregunta no es sencilla y dependerá de varios factores como el impacto productivo que el virus del
1. Nieuwenhuis, N et al., 2012. Economic analysis of outbreaks of porcine reproductive and respiratory syndrome virus in nine sow herds. The Veterinary record. 170. 225. 0.1136/vr.100101.
2. Miranda et al Evaluation of the economic impact of the PRRS virus in the nursery phase. ESPHM 2021. Pag 146.
3. Martín-Valls, G.E. et al Introduction of a PRRSV-1 strain of increased virulence in a pig production structure in Spain: virus evolution and impact on production. Porc Health Manag 9, 1 (2023). https://doi.org/10.1186/s40813-022-00298-3
4. Torrents, D. et al Improvement of productive parameters after piglet PRRS vaccination. IPVS 2020. Pag 543.
PRRS esté teniendo en esa explotación, las coinfecciones presentes y la naturaleza de la cepa campo. Aun así, las experiencias recogidas desde HIPRA demuestran que cuando se realiza en las condiciones epidemiológicas y clínicas pertinentes, la vacunación de lechones resulta rentable. Un estudio reciente realizado en Francia respondió a esta pregunta tras la aplicación de un protocolo de estabilización en una granja de ciclo cerrado en una zona de alta densidad porcina. El protocolo incluía, entre otras medidas, la inmunización de nulíparas (2 dosis), cerdas (cada 4 meses) y lechones (dos dosis) con vacuna viva. Tras la estabilización y como consecuencia la mejora de los parámetros productivos y de crecimiento de los animales (tabla), así como de la reducción de los costes de medicamentos, se estimó un retorno a la inversión de la vacunación de 4,2 € por cerdo7. Estos resultados confirman que la vacunación de lechones con Unistrain® PRRS es una herramienta útil y rentable para reducir el impacto productivo y económico, así como la presión de infección en granjas infectadas, siempre que se utilice y adapte a las necesidades de cada granja y siempre que esta se complete con medidas de manejo y bioseguridad dentro de un plan de control.
Tabla. Evolución de los parámetros reproductivos, productivos y económicos antes y después de la estabilización.
5. Nilubol, D et al. Evaluation of ASF and PRRS virus transmission between pigs when using conventional needles and a needle-free device. IPVS 2022, Pag 677.
6. Antoni Dalmau et al. Intramuscular vs. Intradermic Needle-Free Vaccination in Piglets: Relevance for Animal Welfare Based on an Aversion Learning Test and Vocalizations. Front. Vet. Sci. Volumen 8. 2021. https://doi.org/10.3389/ fvets.2021.715260
7. Lebret, A et al. Economic impact of a porcine reproductive and respiratory syndrome (PRRS) stabilization program in a farrow-to-finish farm using mass vaccination with a modified live vaccine and strict biosecurity measures. ESPHM 2022, pag 76.
Parámetro Antes de
estabilización Tras
estabilización Tasa de fertilidad 90,16 % 95,14 % Índice de conversión 2,74 2,63 Costes veterinarios 9,15 € 6,40 € 50 40 30 20 10 0 Mortalidad (%) Antes de vacunar 1er mes Unistrain® PRRS 2º mes Unistrain® PRRS Siguientes meses Unistrain® PRRS
la
la
4,06 16,09 14,96 6,55
* * * * 56 ■ SUIS Nº 195 Marzo 2023 I+D EMPRESAS I HIPRA

Estrategias para optimizar la funcionalidad gastrointestinal en lechones
Optimizar la función intestinal de los lechones es clave para minimizar la diarrea posdestete y ayudar a evitar el uso de antibióticos. Una estrategia dual puede ayudar a optimizar la función intestinal: respaldar la funcionalidad gastrointestinal y crear un entorno menos favorable para los patógenos.
La disminución del rendimiento durante las primeras etapas en la vida un lechón puede comprometer el resultado en las fases posteriores de crecimiento y finalización. Un lechón resiliente está bien equipado para resistir los desafíos futuros y está mejor capacitado para alcanzar su potencial genético.
Para que los productores críen cerdos sanos y eviten el uso de antibióticos, es fundamental que el lechón tenga una funcionalidad gastrointestinal óptima. Sin embargo, en torno al destete existen importantes desafíos que dificultan el logro de este objetivo. La funcionalidad gastrointestinal óptima es una situación en la que el bienestar, la salud y el rendimiento

del cerdo no se ven limitados por la disfunción intestinal (Celi et al., 2017). Para lograr una funcionalidad gastrointestinal óptima, debe haber una digestión y absorción efectivas del alimento, lo que requiere una microbiota normal y estable, una estructura y función apropiadas de la mucosa y un sistema inmunitario equilibrado. El apoyo al lechón en el destete comienza con la protección del intestino. El intestino proporciona cuatro funciones importantes: regula la absorción de nutrientes y líquidos, gestiona la tolerancia inmunitaria, proporciona una defensa contra las infecciones y proporciona una barrera contra el entorno externo. En la naturaleza, el lechón se desteta durante varias semanas en un proceso gradual y prolongado que permite el pleno desarrollo de estas funciones. Sin embargo, en la producción comercial, el proceso de destete es un evento abrupto de un día que presenta muchos desafíos para las cuatro funciones esen-
ciales del intestino. Todo ello culmina en el problema más comúnmente reportado en cerdos destetados a nivel mundial: la diarrea posdestete, derivada del síndrome del intestino permeable.
SÍNDROME DEL INTESTINO PERMEABLE
El síndrome del intestino permeable se caracteriza por la hiperpermeabilidad del epitelio intestinal. Una falla en la funcionalidad de la unión estrecha da como resultado un aumento en la transferencia paracelular de compuestos nocivos (como bacterias y nutrientes no digeridos) desde la luz intestinal. Estos compuestos nocivos activan la cascada de citocinas proinflamatorias NFkB que provocan un aumento de la producción de especies reactivas de oxígeno (ROS), como los peróxidos, para combatir los microbios, pero que también pueden causar daños colaterales a las células. Los patógenos, como la E. coli enterotoxigénica (ETEC), pueden adherirse a las células intestinales y producir toxinas que inducen una pérdida de agua y electrolitos de las células, lo que provoca diarrea (Gresse et al., 2017). Además de la diarrea, el productor puede ver fácilmente otros resultados de la infección entérica, como la reducción del consumo de alimento, pérdida de peso, fiebre, poca eficiencia alimenticia y falta de uniformidad. Sin embargo, lo que no se ve fácilmente es el aumento subyacente de la producción de citocinas proinflamatorias y proteínas de fase aguda que desencadena la infección entérica. La producción de estos compuestos modifica cualitativa y cuantitativamente de forma significativa los requerimientos de nutrientes específicos como aminoácidos, vitaminas, minerales, antioxidantes y lípidos.
Neil Gannon. DSM Global Swine Technical Manager Adaptación de José Miguel Contreras. DSM Technical, Species Expert, Swine
58 ■ SUIS Nº 195 Marzo 2023 I+D EMPRESAS I DSM
Gabriela Bertolini/shutterstock.com
La gravedad del síndrome del intestino permeable se ve afectada por factores directos e indirectos. Los factores directos incluyen alérgenos y antígenos que activan la cascada de citocinas proinflamatorias que causan inflamación intestinal. Los alérgenos pueden tener su origen en el pienso y los más frecuentes en las dietas de los lechones tienen su origen en la harina de soja. Los antígenos también pueden originarse en el alimento e incluir componentes como las micotoxinas, pero también pueden originarse en la luz intestinal a partir de desechos celulares (peptidoglicanos) que se originan en las paredes celulares de bacterias grampositivas muertas (McCormack et al., 2020). Los factores indirectos que contribuyen a la gravedad del síndrome del intestino permeable son los facilitadores de un entorno intestinal que favorece el crecimiento de patógenos, tanto en términos de los sustratos que necesitan para crecer, como del entorno en el que viven. La estrategia dual para reducir el síndrome del intestino permeable se describe en la figura 1.
ESTRATEGIAS PARA APOYAR LA FUNCIONALIDAD GASTROINTESTINAL ÓPTIMA
Desactivar la glicinina con una proteasa específica
Un alérgeno importante y común que se encuentra en muchos alimentos para cerdos son las proteínas de soja denominadas glicinina y B-conglicinina. Estas dos proteínas suelen representar alrededor del 75 % de la fracción proteica de la soja
o del 25 al 35 % del peso de la semilla (Hammond et al., 2016). Estos alérgenos de la soja aumentan la permeabilidad del intestino, lo que induce una respuesta inmunitaria local que conduce a la sensibilización, lo que da como resultado un deterioro de la homeostasis y la funcionalidad intestinal. Se ha demostrado que el uso de una proteasa dirigida para desactivar la glicinina reduce las citocinas proinflamatorias en el plasma y reduce la permeabilidad de la barrera yeyunal (Park et al., 2020).
Desactivar las micotoxinas
También se sabe que las micotoxinas, en particular compuestos como el deoxinivalenol y las fumonisinas, interrumpen la función de las proteínas de unión estrecha y facilitan aún más la absorción de otras micotoxinas y compuestos del intestino. Se ha demostrado que la desactivación eficaz de las micotoxinas mejora la ganancia de peso de los lechones y previene el daño de la histología intestinal (Maching, 2015).
Aplicar una muramidasa para reducir los efectos negativos de los peptidoglicanos
Los peptidoglicanos (PGN) son un componente principal de las paredes celulares bacterianas (figura 2) y son significativos en las bacterias grampositivas, pero también se encuentran en las bacterias gramnegativas. Los peptidoglicanos son un componente clave del mecanismo por el cual el intestino reconoce la presencia de bacterias e inicia una respuesta
inmunológica (Wolf y Underhill, 2018). Cuando las bacterias mueren, los desechos celulares, incluido el PGN, pueden desencadenar una respuesta inmunitaria al unirse al receptor de las células epiteliales Toll tipo 2 (TLR-2). Los procesos inflamatorios resultantes pueden conducir a una reducción en la absorción de nutrientes en el intestino delgado y exacerbar el flujo de nutrientes a tramos posteriores del intestino donde pueden crecer los patógenos. La aplicación de una muramidasa específica puede escindir los PGN, creando dipéptido de muramilo (MDP) y reduciendo así los efectos negativos de los PGN. Además, la célula epitelial capta MDP y activa otro receptor, el NOD-2. Cuando los receptores NOD-2 se activan, inician un efecto antiinflamatorio a través de su papel en la protección de la barrera y la vigilancia de la pared celular. Por lo tanto, el uso de una muramidasa puede ayudar a equilibrar los efectos proinflamatorios y antiinflamatorios que crean los desechos bacterianos en el intestino y mejorar la ganancia media diaria de los lechones (Wang et al., 2021; EFSA, 2021).
ESTRATEGIAS PARA CREAR UN AMBIENTE INTESTINAL MENOS FAVORABLE PARA LOS PATÓGENOS
Usar enzimas para mitigar el riesgo de E. coli y mejorar la digestibilidad de los nutrientes
Además de los alérgenos, la harina de soja también contiene inhibidores de la
Directos
Activadores de la cascada de citoquinas proinflamatorias que causan inflamación intestinal (alergenos y antígenos).
■ Procedentes de la luz intestinal. Como bacterias
Gram – y restos celulares de Gram + (peptidoglicanos)
■ Procedentes de alimentos como micotoxinas y alergenos de la harina de soja
Indirectos
Facilitadores de un ambiente intestinal que apoya el crecimiento de patógenos
■ Abundancia de nutrientes no digeridos. En particular, proteínas, fibra viscosa y fitato
■ Ambiente de pH intestinal óptimo (neutro). Favorece la proliferación de patógenos y no la inhibición
Figura 1. Estrategia dual para reducir el síndrome del intestino permeable.
SUIS Nº 195 Marzo 2023 ■ 59 I+D EMPRESAS I DSM
Síndrome de intestino permeable
proteasa que interfieren con la actividad de la tripsina o la quimotripsina, enzimas endógenas esenciales para la digestión de proteínas. Si bien el tratamiento térmico durante la producción de harina de soja puede mitigar algunos de los efectos de los inhibidores de la proteasa, si la destrucción de estos inhibidores no es completa, la proteína no digerida en la dieta puede fermentarse en el intestino grueso y conducir a la producción de metabolitos tóxicos que contienen nitrógeno y van a producir diarrea (Jha y Berrocoso, 2016). También se ha demostrado que la presencia de fibra que aumente la viscosidad favorece el crecimiento de bacterias gramnegativas que se sabe que tienen efectos negativos sobre la funcionalidad gastrointestinal y la salud general del cerdo (Hopwood et al., 2004). Se ha demostrado que el uso de enzimas dirigidas a los polisacáridos no amiláceos de la dieta reduce la viscosidad de la digesta, mitiga el riesgo de crecimiento de E. coli patógena y conduce a una mejor digestibilidad de los nutrientes, lo que da lugar a un incremento del rendimiento animal, como lo demuestran las mejoras en la ganancia media diaria y las reducciones en la diarrea acuosa (Kim et al., 2011).
Desactivar el efecto antinutricional del fitato
El efecto antinutricional del fitato se debe a su capacidad de formar complejos insolubles con minerales y proteínas convirtiéndolos en no asimilables por el organismo bajo condiciones fisiológicas y aumentando el flujo de nutrientes al intestino grueso (Woyengo y Nyachoti, 2013). Además, la alta densidad de carga negativa del ácido fítico da como resultado una fuerte formación de complejos de cationes como el hierro, el calcio, el cinc y el magnesio (Humer et al., 2014) y, por lo tanto, puede proporcionar una fuente valiosa de hierro para apoyar el crecimiento de patógenos en el intestino posterior Se ha demostrado que el uso de fitasas para hidrolizar el ácido fítico y, por lo tanto, reducir los efectos negativos del ácido fítico sobre la digestibilidad de nutrientes y la unión a minerales es una estrategia eficaz (Lee y Stahl, 2001).
Cambiar el pH del intestino para reducir el crecimiento de patógenos Cambiar el entorno de pH del intestino para favorecer la inhibición en lugar de la proliferación es otra estrategia eficaz para reducir el crecimiento de pató-
genos. Se ha demostrado que el uso de ácido benzoico purificado para reducir el pH del contenido intestinal a pH 5,5 reduce eficazmente el crecimiento de E. coli en comparación con otros ácidos. Además, cuando se añadió ácido benzoico purificado a las dietas de los lechones, se observó una respuesta significativa y dependiente de la dosis sobre el pH en el estómago y el intestino delgado (Knarreborg et al., 2002).

CONCLUSIÓN
La reducción de la necesidad de medicamentos después del destete se basa en proteger al lechón contra la disfunción intestinal que causa diarrea y en apoyar la funcionalidad gastrointestinal óptima. El logro de este objetivo requiere un enfoque holístico que no dependa de una estrategia de un solo producto, sino que abarque un enfoque integral de la nutrición. Por el contrario, para hacer frente a este desafío, el éxito radica en el uso de soluciones hechas a la medida, que creen un ambiente intestinal que no sea favorable para el crecimiento de patógenos y que no aporte nutrientes sin digerir que van a usar los patógenos, así como la desactivación de los factores antinutricionales del alimento y el microbioma (PGN).
Fuente. DSM Nutritional Products.
Figura 2. El peptidoglicano es un componente importante de la pared celular bacteriana.
Lipopolisacárido (LPS)
Gram – Gram +
Proteína de membrana
Peptidoglicano (PGN)
Ácido teicoico de pared
Peptidoglicano (PGN)
Bicapa lipídica
60 ■ SUIS Nº 195 Marzo 2023 I+D EMPRESAS I DSM
Bicapa lipídica

La importancia de realizar una adecuada desinfección de los transportes de cerdos
La amenaza de la PPA o del PRRS con sus nuevas cepas mucho más virulentas obliga a reflexionar sobre el elevado riesgo que supone la entrada y diseminación de estas enfermedades en las granjas. Por esta razón, se debe incrementar el nivel de alerta y las medidas de control, principalmente la limpieza y desinfección.
Departamento Técnico Biocidas Biodegradables ZIX, SL
El desarrollo del sector porcino provoca un incremento en la concentración de explotaciones porcinas de gran volumen, un incremento de la densidad de la población porcina en determinados mercados y regiones y, por consiguiente, la existencia de un gran tránsito de vehículos y personas entre los núcleos de producción. El impacto positivo todos lo conocemos, pero esta situación también tiene como consecuencia directa el incremento de problemas patológicos. En muchas ocasiones, se tiene que hacer frente a nuevas enfermedades o a enfermedades conocidas reemergentes.

Varios de estos problemas han complicado o están actualmente dificultando todo lo positivo que ha llevado la profesionalización y el desarrollo del sector. Algunas de las patologías se han conseguido controlar o erradicar gracias al incansable trabajo de toda la cadena de producción, pero, desafortunadamente, otras muchas patologías todavía no han podido ser vencidas y continúan requiriendo mucho esfuerzo por nuestra parte.
GRANDES AMENAZAS DEL SECTOR
En la actualidad, son varias las entidades patológicas que más azotan al sector porcino. Por un lado, tenemos al PRRS (Síndrome Reproductivo y Respiratorio Porcino), provocando cada vez más efectos devastadores con sus nuevas cepas, mucho más virulentas que sus predecesoras, afectando a granjas de madres, destetes e incluso engordes. Por otro, tampoco podemos olvidar a otro de los enemigos del sector, la PPA (Peste Porcina Africana), la
cual también provoca graves consecuencias socioeconómicas en los países afectados.
Todo ello nos hace reflexionar que el riesgo de entrada y diseminación de estas enfermedades es muy alto y debemos incrementar el nivel de alerta y, en consecuencia, las medidas de control (limpieza y desinfección) para evitar la temida entrada de las enfermedades.
¿CUÁL ES LA SOLUCIÓN?
El remedio tiene como pilar fundamental la bioseguridad; debemos continuar mejorando y seguir un exquisito cumplimiento de las medidas de bioseguridad para evitar la llegada y/o expansión de las enfermedades que potencialmente puedan entrar en el área geográfica, granja
o nave. Dentro de todas las medidas de bioseguridad, destacamos la limpieza y desinfección como medidas clave.
¿CUÁL ES LA REALIDAD DE LAS GRANJAS?
Partiendo de la importancia clave la limpieza y desinfección, las herramientas esenciales para la lucha con las enfermedades son la máquina de presión junto con el detergente y la mochila o nebulizadores de desinfección preparados con desinfectante de amplio espectro activo. Pero, si profundizamos en el análisis de nuestra preparación y la situación tanto de granjas como de vehículos de transporte, la realidad es otra. A continuación, se detallan dos estudios realizados en España.
I+D EMPRESAS I BIOCIDAS BIODEGRADABLES ZIX Ggamies/shutterstock.com 62 ■ SUIS Nº 195 Marzo 2023
ESTUDIO 1
Análisis cualitativo de preparación/ control de las granjas y análisis cuantitativo de la contaminación de los vehículos de transporte Análisis 1 (cualitativo). Preparación y control de la desinfección de las granjas
Este primer estudio tiene como objetivo conocer la situación actual de preparación y el control para la desinfección de los lugares como granjas, con el fin de determinar si las operaciones de limpieza actuales están siendo eficaces. De esta manera, se muestrearon cincuenta granjas porcinas (madres, engorde y destetes), analizando mochilas de desinfección preparadas con desinfectante (existencia o no); actividad del desinfectante dentro de las mochilas (desinfectante activo o no); y desinfección previa a la entrada de los vehículos que acceden a las granjas (realización de la desinfección o no).
En este primer análisis se evidenció lo siguiente:
■ El 40 % del total de mochilas de desinfección revisadas estaban vacías.
■ Del 60 % de las mochilas llenas, el 55 % no había cambiado el desinfectante durante la última semana, es decir, el desinfectante no estaba en condiciones óptimas para su cometido.
■ Solo el 33 % de todas las mochilas testadas contaban estaban listas para cumplir con su cometido.
Por lo que respecta a los vehículos externos que entran diariamente a las instalaciones (coches, furgones y camiones de transporte), los datos también fueron preocupantes, ya que se pudo comprobar que:
■ Un 95 % de las granjas aceptaban que los vehículos que entraban en su instalación no se desinfectaran.
Análisis 2 (cuantitativo).
Contaminación de los vehículos de transporte
También quisimos comprobar la contaminación de los camiones a la salida de los centros de desinfección, entradas a mataderos y entradas a granjas, ya que acceden a estos lugares después de ser desinfectados. Con este análisis se quiso revisar la calidad de las desinfecciones realizadas y el riesgo existente, haciendo las comprobaciones en los diferentes lugares. Para ello, se realizaron análisis microbiológicos de los vehículos de transporte de animales en tres lugares diferentes: cuatro mataderos
(entrada); cuatro centros de desinfección de transporte (salida) y cincuenta granjas (entrada). De esta manera, se analizaron 63 camiones de transporte porcino, 21 a la salida de los centros de desinfección, 21 a la salida de los mataderos y 21 a la entrada de las granjas. Se recogieron muestras en la plataforma elevadora, en el inicio de la caja y en el final de la misma.
El método de análisis empleado fue la lectura de lectura ATP (Adenosín Trifosfato o Trifosfato de Adenosina y las muestras se recogieron sobre una superficie de 33 cm2 con esponjas para realizar cultivos de enterorobacterias. El criterio para la clasificación de los resultados expresados en UFC (Unidades Formadoras de Colonias) por cm2 es como sigue:
■ 0-100 UFC/cm2: desinfección correcta.
■ 101-200 UFC/cm2: desinfección insuficiente.
■ 201-500 UFC/cm2: desinfección mala.
■ 501- > 1.000 UFC/cm2: desinfección muy mala.
Como resultado, se encontró que, de un total de 63 camiones analizados, únicamente en el 4,67 % de los casos se consiguió una desinfección correcta (0-100 UFC/cm2). El resto de los análisis mostraron valores de desinfección malos (201-500 UFC/cm2) o insuficientes (101-200 UFC/cm2).
Por tanto, se puede concluir que:
■ El actual plan de bioseguridad de las granjas estudiadas tiene deficiencias que suponen un riesgo importante para la seguridad.
■ El 95,33 % de los camiones analizados y previamente desinfectados estaban contaminados con valores malos (201500 UFC/cm2 y 101-200 UFC/cm2).

ESTUDIO 2
Análisis de la desinfección principal de los camiones y protocolo de segunda desinfección por nebulización con Zix Virox Ante los resultados obtenidos en el primer estudio experimental, surge la necesidad de desarrollar un protocolo de acción complementario para el refuerzo de la bioseguridad en el transporte porcino que asegure una desinfección adecuada. Este segundo estudio tiene como objetivo reforzar y asegurar una correcta desinfección de los camiones de transporte por medio del desarrollo de un protocolo de desinfección adecuado. El estudio fue realizado por el Grupo de Saneamiento Porcino de Girona (GSP) en colaboración con Biocidas Biodegradables Zix. El ensayo consistió en el desarrollo de un protocolo de segunda desinfección por nebulización con Zix Virox y la comparación de su eficacia con otros protocolos de desinfección actuales utilizados en las granjas. El lugar de muestreo fue una granja porcina con centro de desinfección en la que se analizaron la plataforma elevadora, el inicio y el final de la caja de los camiones. La primera técnica de desinfección (Técnica 1) consistió en la desinfección por remojo mediante manguera con desinfectante a
I+D EMPRESAS I BIOCIDAS BIODEGRADABLES ZIX
SUIS Nº 195 Marzo 2023 ■ 63
Ggamies/shutterstock.com
presión (ya realizada en los centros de desinfección). Es este caso se empleó un desinfectante genérico (glutaraldehído 15,00 % y cloruro de didecil dimetil amonio 10,00 %; desinfectante A), utilizado en los centros de limpieza y desinfección, y aplicado a una dilución al 6 %. El tiempo de contacto del desinfectante fue de 48 horas. La segunda técnica (Técnica 2) se fundamentó en la desinfección por nebulización/pulverización con el desinfectante B (Zix Virox; peróxido de hidrógeno 25 % y ácido peracético 5 %), aplicado a una dilución al 2 %. El tiempo de contacto del desinfectante fue de 5 minutos. La recogida de las muestras se llevó a cabo sobre una superficie de 33 cm2 con esponjas para realizar cultivos de enterorobacterias. Se tomaron muestras y se realizaron análisis para cada uno de los tres elementos (plataforma elevadora, inicio de caja, final de caja), y para cada una de las técnicas de desinfección. Se realiza igualmente un análisis inicial de los elementos sin desinfectar. Por tanto, se resumen las analíticas en tres situaciones distintas que permiten comparar las diferentes técnicas de desinfección utilizadas:
■ Situación inicial. Se analizan valores de contaminación en los elementos limpios y no desinfectados. De esta manera, se conocen los valores numéricos de
partida, que arrojan datos de contaminación por encima de 3.000 UFC/cm2

■ Situación 2. Elementos limpios y desinfectados con la Técnica 1 y el desinfectante A (con base de glutaraldehído y amonio).
■ Situación 3. Elementos (plataforma elevadora, inicio de caja, final de caja) limpios y desinfectados previamente con Técnica 2 y el desinfectante B (Zix Virox).
El método de análisis empleado fue la lectura de lectura ATP (Adenosín Trifosfato o Trifosfato de Adenosina y los resultados se expresan en UFC (Unidades Formadoras de Colonias) por cm2 como sigue:
■ 0-100 UFC/cm2: desinfección correcta.
■ 101-200 UFC/cm2: desinfección insuficiente.
■ 201-500 UFC/cm2: desinfección mala.
■ 501- > 1.000 UFC/cm2: desinfección muy mala.
Con el uso de técnica 1 y el desinfectante A al 6 % se obtiene un resultado de desinfección insuficiente en el inicio de caja (101200 UFC/cm2), una desinfección muy mala en el final de caja (501- > 1.000 UFC/cm2) y una desinfección muy poco significativa en la plataforma elevadora, llegando a valores por encima de 1.500 UFC/cm2 Cabe destacar que el trabajo del proceso de limpieza y desinfección se valoró
subjetivamente y se certificó que está bien realizado, aunque desinfectar sobre mojado y con manguera podría diluir el desinfectante.
En el caso de la Técnica 2, una vez realizada la limpieza, se aplica el desinfectante B (Zix Virox).por nebulización al 2 % sobre los elementos plataforma elevadora, inicio de caja, final de caja. Los valores de contaminación de todos los lugares analizados llegan a un nivel desinfección correcta 0-100 UFC/cm2, muy próximos a 0.
CONCLUSIONES
■ La eficacia de la desinfección depende del tipo de desinfectante, la materia activa, la concentración y el tiempo de contacto.
■ La aplicación de un desinfectante no asegura la completa desinfección de las superficies.
■ El desinfectante A con base en Glutaraldehído 15,00 % y Cloruro de Didecil Dimetil Amonio 10,00 % al 6 % de concentración y usado por remojo no es eficaz, a pesar de tener tiempos de contacto mayores (48 horas) con la superficie a desinfectar.
■ La eficacia de desinfección de Zix Virox al 2 % es total tras una nebulización de 5 minutos, siendo por tanto la combinación de producto Zix Virox + nebulización la única que ha demostrado una desinfección total en el presente estudio.
Zix Virox es un desinfectante líquido de amplio espectro, altamente eficaz, viricida, bactericida y fungicida 100 % biodegradable, con certificado Ecocert, de uso profesional, no cancerígeno. Además, cuenta con pruebas de eficacia frente a PRRS (0,2 %) y frente a PPA (1 %). Este estudio experimental pone de manifiesto que todavía existe mucho camino que recorrer en la mejora de medidas de bioseguridad en muchas granjas porcinas. Todavía existen muchas explotaciones vulnerables a sus devastadores efectos de los virus como PPA o PRRS. En lugares con grandes concentraciones de animales las medidas preventivas son nuestro mayor aliado. La mejora de los programas de bioseguridad es la responsabilidad de todos y podemos ayudar trabajando desde nuestras explotaciones hasta nuestros colaboradores y vecinos.
Todos los datos de este estudio pueden ser consultados bajo solicitud a Biocidas Biodegradables ZIX, SL.
I+D EMPRESAS I BIOCIDAS
BIODEGRADABLES ZIX
Thammachak Sotiya/shutterstock.com 64 ■ SUIS Nº 195 Marzo 2023

Avance del próximo número
ARTÍCULOS
Principales medidas de bioseguridad preventivas frente a la peste porcina africana ¿Cómo podemos contribuir a prevenir su dispersión?
Bioseguridad y control microbiológico en granjas porcinas
CON NOMBRE PROPIO
¿Qué nos falta en bioseguridad?
CURSOS DE FORMACIÓN
Evolución de las enfermedades gastroentéricas en función del nuevo escenario de producción
3ª Parte: El papel de los biomarcadores
Gestión de explotaciones porcinas
3ª Parte: Eficiencia reproductiva
Suscripción al programa de formación Suis
Modalidad de suscripción (señale con una X la elegida)
Suscripción anual. 10 números por 95 €.
Suscripción internacional. 10 números por 130 €.
Datos del suscriptor
Nombre:
1er Apellido:
2º Apellido:
Empresa (si procede): Año de nacimiento:
Dirección: Código Postal:
Localidad: Provincia: País:
CIF/NIF: Teléfono: E-mail:
Profesión: Veterinario Ingeniero Ganadero Otra:
Forma de pago (señalar y cumplimentar)
Contra reembolso Domiciliación bancaria:
Tarjeta de crédito: Visa: Master Card: Otra:
Nombre del titular:
Señale si desea que le sea enviada la factura de esta suscripción: Sí No
Para suscripciones internacionales: Cheque bancario a favor de Grupo Asís Tarjetas (cumplimentar apartado Tarjeta de crédito)
Actividad profesional (señale con una X lo que corresponda)
Caducidad: /
Firma (imprescindible):
Cooperativa Integradora Comercial Granja Formulación Delegado Marketing Compras Dirección Docencia Administración Investigación Otra
Clínica libre ADS
De acuerdo con la normativa vigente en materia de protección de datos Grupo Asís Biomedia, SL., es responsable del tratamiento de sus datos personales con la finalidad de enviarle comunicaciones postales de nuestras revistas especializadas, así como otras comunicaciones comerciales o informativas relativas a nuestras actividades, publicaciones y servicios, o de terceros que puedan resultar de su interés en base a su consentimiento. Para ello, Grupo Asís podrá ceder sus datos a terceros proveedores de servicios de mensajería. Podrá revocar su consentimiento, así como ejercer sus derechos de acceso, rectificación, supresión, oposición, limitación y portabilidad enviando un correo electrónico a protecciondatos@grupoasis.com, o una comunicación escrita a Grupo Asís en Centro Empresarial El Trovador, planta 8, oficina I, Plaza Antonio Beltrán Martínez 1, 50002, Zaragoza (España), aportando fotocopia de su DNI o documento identificativo sustitutorio e identificándose como suscriptor de la revista. Asimismo, si considera que sus datos han sido tratados de forma inadecuada, podrá presentar una reclamación ante la Agencia Española de Protección de Datos (C/ Jorge Juan,
Puede realizar la suscripción cómodamente por: Correo
Enviar original o fotocopia de este cupón a la dirección abajo indicada
Teléfono +34 976 461 480 Centro Empresarial El Trovador, planta 8, oficina I - Plaza Antonio
Martínez, 1 - 50002
Tel.: +34 976 461 480 - Email: suscripciones@grupoasis.com - store.grupoasis.com
Beltrán
Zaragoza
6. 28001 –
Madrid www.agpd.es).
Web store.grupoasis.com






 Francisco Fueyo Director de la Unidad de Animales de Producción Zoetis España
Francisco Fueyo Director de la Unidad de Animales de Producción Zoetis España











 Figura 2. Ejemplos de secuenciación de la ORF5. Errores de interpretación debido a recombinaciones.
Ejemplo 1. ORF5 recombinante
Ejemplo 2. Cepa recombinante con ORF5 de una solo cepa parental
Figura 2. Ejemplos de secuenciación de la ORF5. Errores de interpretación debido a recombinaciones.
Ejemplo 1. ORF5 recombinante
Ejemplo 2. Cepa recombinante con ORF5 de una solo cepa parental





 Figura 1. Histograma de los lechones nacidos muertos por genética en porcentaje.
Figura 1. Histograma de los lechones nacidos muertos por genética en porcentaje.

Camo
Jefe del Área Agroalimentaria de Feria de Zaragoza y Director de la Feria Internacional para la Producción Animal, FIGAN
Camo
Jefe del Área Agroalimentaria de Feria de Zaragoza y Director de la Feria Internacional para la Producción Animal, FIGAN










































